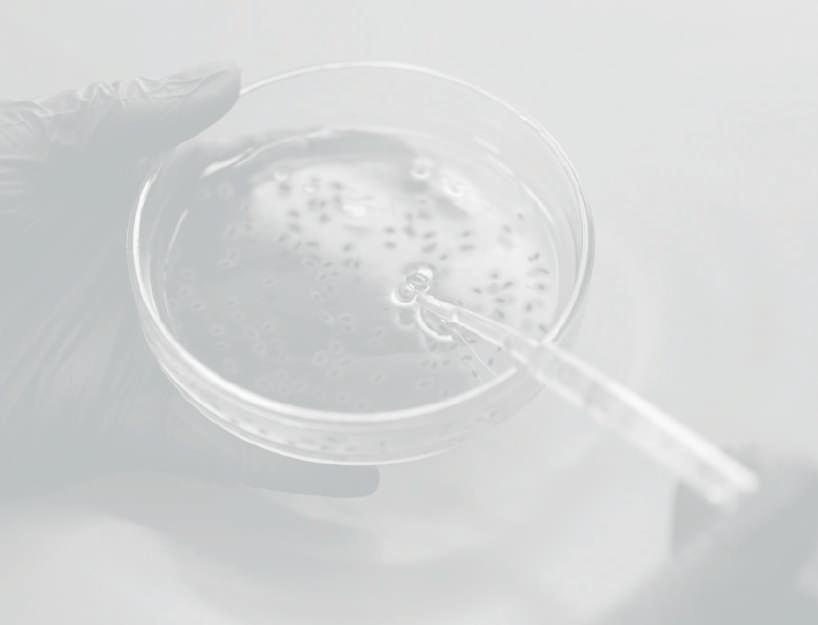

![]()





No es norma de la casa hablar de sí misma, pero por esta vez nos gustaría saltárnosla para celebrar, con lectores y anunciantes, que esta revista salió por primera vez en el bimestre marzo/abril de 1969. En el mundo de los laboratorios y los análisis de todo tipo, pocos hitos son tan significativos como el de llegar a la edición nº 500 cuando hablamos de una publicación técnica especializada. Técnicas de Laboratorio ha sido durante todas estas décadas un referente para los profesionales del sector, ofreciendo información valiosa sobre las últimas innovaciones acerca del equipamiento y los avances tecnológicos que impulsan el sector en general.
Hoy celebramos -con orgullo- la publicación de nuestro número 500, logro que refleja no solo el paso del tiempo, sino también el compromiso continuo con la excelencia, la innovación y el servicio al sector.
Desde su primera portada, esta revista ha sido testigo de los cambios en la industria y ha desempeñado un importante papel en la difusión de conocimientos técnicos y avances de todo tipo. A lo largo de estos 500 números, hemos estado al lado del crecimiento y la transformación del laboratorio, proporcionando información para optimizar los procesos y mejorar la calidad de los productos y servicios.
En sus primeros años, Técnicas de Laboratorio se centraba, con periodicidad bimestral, en las bases técnicas del sector, con artículos sobre nuevos métodos analíticos, los equipamientos, la instrumentación y los avances vertiginosos que regularmente se iban plasmando en sus páginas. Con el paso de los años, la revista se fue adaptando, y lo sigue haciendo, a los nuevos retos y oportunidades de la industria, incorporando contenidos sobre digitalización, automatización y sostenibilidad, sin dejar de lado, naturalmente, las últimas innovaciones en equipos y tecnología. También hace muchos años que pasó a ser una publicación mensual, para hacer más fluido el contacto con los lectores y ofrecer a los anunciantes un camino más rápido y directo hacia el mercado, máxime en un sector cuyos salones profesionales importantes se celebran cada dos o tres años. Ni que decir tiene que los medios electrónicos han facilitado

Portada del número 1 de la revista, correspondiente a marzo / abril de 1969. Se aprecia el sello que representa el control del Ministerio de Información y Turismo de entonces
enormemente esta fluidez, que se manifiesta en newsletters y otros formatos que complementan a la perfección el espíritu comunicativo de la revista desde hace ahora 56 años.
Técnicas de Laboratorio no solo ha sido y sigue siendo una plataforma informativa de primer orden, sino también un punto de encuentro para los profesionales del sector. Gracias a la colaboración con expertos, investigadores y empresas líderes, hemos logrado ofrecer contenidos fundamentales para el desarrollo de soluciones técnicas y el impulso de la competitividad de las firmas que se dedican a esta actividad.
Alcanzada la edición nº 500, queremos agradecer a nuestros lectores, colaboradores y todas las empresas que han confiado en nosotros su apoyo constante. Este hito no solo es un reconocimiento al esfuerzo y dedicación de quienes han formado parte de Técnicas de Laboratorio a lo largo de todos estos años, sino también un compromiso con el futuro del sector. Queremos recordar asimismo a todos los compañeros de viaje que nos han dejado a lo largo de estos primeros 500 ejemplares de andadura. Seguiremos, con el mismo empeño, ofreciendo información relevante, actualizada y de calidad, contribuyendo al crecimiento de la industria en un mundo cada vez más competitivo y tecnológico.
Publica, S.L.




144 novedades
158 consumibles
Sellado y despegado de PCR/microplacas para laboratorios de alto rendimiento
Derek Thomas
162 entrevista

Diana Morant, ministra de Ciencia, Innovación y Universidades
164 el número 500
Del contexto inicial hasta hoy
167 dossier
Quinientos números… desde 17 puntos de vista
177 expoquimia
Sesenta años al servicio de la industria química española
182 entrevista
Ricardo Díaz Martín, decano-presidente del Consejo General de Colegios Oficiales de Químicos de España
186 instituciones
El CSIC, la entidad que vela por la ciencia y la técnica en España
Xavier Bautista
190 noticias



197 guía del comprador

Lynx, nueva marca especializada en microscopía
Lynx es una nueva propuesta en el campo de la microscopia y la captura de imágenes científicas. Su enfoque combina precisión óptica, diseño ergonómico y facilidad de uso, con una filosofía clara: ofrecer equipos fiables, bien construidos y con precios justos. Dirigida a entornos educativos, clínicos y de investigación, la marca busca acompañar el trabajo diario en el laboratorio con soluciones accesibles y técnicamente sólidas.
- Microscopio biológico Quantum BM. Pensado para la enseñanza y el diagnóstico, este instrumento ofrece una observación clara y confortable. Equipado con óptica corregida al infinito y objetivos plano-acromáticos, proporciona imágenes nítidas y fieles en color. Su sistema de enfoque micrométrico (0,002 mm) y condensador Abbe preajustado facilitan un trabajo preciso con mínima intervención técnica. Constituye una excelente opción para instituciones que buscan rendimiento y durabilidad sin comprometer su presupuesto.
- Estereomicroscopio L90, modelo ideal para estudios en 3D de muestras voluminosas. Su sistema zum de 0.7X a 4.5X permite ampliar con fluidez sin perder el enfoque. Con una distancia de trabajo de 100 mm y doble iluminación led (incidente y transmitida),
se adapta a múltiples aplicaciones: biología, industria, electrónica o control de calidad. Su estructura robusta y versatilidad lo convierten en una herramienta útil para diversos entornos de análisis.
- SNAP y SNAP Connect. Las cámaras de la serie SNAP, disponibles en versiones USB y con conectividad múltiple (SNAP Connect), están diseñadas para facilitar la digitalización y el análisis de imágenes microscópicas con alta fidelidad. Estas cámaras incorporan sensores CMOS Sony de excelente sensibilidad y un motor ISP integrado que asegura una reproducción precisa del color y gran nitidez en las imágenes. El software incluido permite mucho más que simplemente capturar: posibilita realizar mediciones en pantalla, ajustes finos de imagen, grabaciones de vídeo, así como generar imágenes de barrido (image stitching), uniendo múltiples campos visuales en una sola imagen compuesta de alta resolución. Además, es posible trabajar con captura directa a tarjeta SD (en el caso de SNAP Connect), visualizar en pantallas HDMI sin necesidad de PC y controlar con el ratón todos los parámetros con una interfaz intuitiva. Gracias a su compatibilidad multiplataforma y soporte de SDKs para Windows,

macOS, Linux y Android, estas cámaras se integran fácilmente en flujos de trabajo científicos o educativos que requieran flexibilidad, calidad y buen precio.
Además de estas series, Lynx cuenta con otros modelos de microscopios ópticos, estereoscópicos y accesorios diseñados para complementar distintos tipos de trabajo en laboratorio. Labbox está construyendo una marca cercana, funcional y al servicio de quienes trabajan todos los días con la ciencia. Se invita a docentes, técnicos y profesionales a conocer más sobre la gama Lynx microscopes en https://labbox.es/etiqueta/lynxmicroscopes/.
www.labbox.es
(Véase anuncio en la sección
Guía del Comprador.)
LEE
Orificios calibrados de precisión
Lee propone una gama de orificios calibrados de precisión que destacan por:
• estar disponibles de acero inoxidable o latón
• servir para instalación en plástico o metal
Agarosa de alta pureza
Epica, S.L., ofrece al mercado agarosa específicamente validada para aplicaciones de biología molecular. Sus principales características son:
· Alta pureza
· Alta resolución en la migración
· Fácil disolución

• con o sin pantalla protectora
• 100% de las piezas testadas en fábrica
• la restricción calibrada con una tolerancia del ±5%.
www.leeimh.com

· Baja electroendósmosis (0,05-0,13)
· Sin DNasa, RNasas y proteasas
· Punto de fusión: 88 °C ± 1,5 °C*
· Punto de gelificación: 36 °C ± 1,5 °C*
. Resistencia del gel, 2.000 g/cm2*.
(*Datos referidos a un gel al 1,5%)


BIOTECH FLUIDICS
Valide el rendimiento de su bomba HPLC
Biotech Fluidics ha lanzado un nuevo kit de caudalímetro que proporciona una validación rápida, precisa y fiable del rendimiento continuo de cualquier bomba HPLC. Todas las separaciones HPLC dependen de un flujo estable de disolvente y, en consecuencia, requieren un rendimiento constante de la bomba del sistema. Hasta ahora, la determinación directa del caudal se ha limitado a la validación del sistema mediante caudalímetros volumétricos o, si se requiere monitorización, mediante el uso de caudalímetros Coriolis. Ambas metodologías tienen limitaciones. Los caudalímetros volumétricos se integran durante un tiempo relativamente largo y un gran volumen, además de no proporcionar datos sobre la variabilidad y la pulsación. Los caudalímetros Coriolis también tienen limitaciones en términos de resolución temporal y son algo caros. Basado en un sensor térmico no invasivo en tiempo real, el caudalímetro de líquido de Biotech Fluidics ofrece una solución elegante para la validación del rendimiento de la bomba HPLC. El kit de validación de bomba HPLC se ha diseñado para aceptar datos sin procesar generados por la aplicación para PC del caudalímetro de líquidos Biotech Fluidics y realiza todos los cálculos de caudal necesarios de forma automática. Todos los datos y parámetros se validan automáticamente para comprobar su idoneidad para su uso y se genera un informe resumido que se puede almacenar o imprimir para tener una documentación en papel. El kit de validación de bomba HPLC incluye un procedimiento operativo estándar (SOP) que detalla todo el protocolo de validación. Además de la validación del rendimiento de la bomba, el kit de validación de bomba HPLC se puede utilizar para controlar los cambios transitorios en tiempo real, incluida la pulsación de la bomba.
Para obtener más información, visite https://biotechfluidics. com/posts/validate-the-performance-of-your-hplc-pump/ o co-

Informe del kit de validación de bomba HPLC
muníquese con Biotech Fluidics (46 300 56 91 80 / + 1-612703-5718; info@biotechfluidics.com).
Biotech Fluidics es un destacado proveedor de soluciones de sistemas fluídicos, componentes de transferencia de líquidos, sistemas de desgasificación y tecnología de laboratorio innovadora para desarrolladores, fabricantes y distribuidores de instrumentos de todo el mundo. Su misión es empoderar a sus clientes mediante el diseño y ensamblaje de productos únicos, siendo un socio fiable, ofreciendo un servicio de primera clase, conocimiento profundo y ofreciendo soporte técnico avanzado para todos los artículos que ofrece.
www.biotechfluidics.com

KERN
Microscopio estereoscópico con zum OZL-45R
Kern presenta una serie de microscopios muy prácticos para el laboratorio, los centros formativos, los controles de calidad y la agricultura.
• Los modelos OZL-45R son microscopios estereoscópicos muy robustos y fáciles de manejar con un gran rango de zum (desde 0,75 a 5x)
• Gracias a su caballete mecánico son especialmente estables
• Son óptimos para lugares de trabajo con un entorno duro como centros formativos, talleres y puntos de montaje y reparación en el sector de la electrónica
• También son ideales para la fabricación y el control de calidad
• Además de unas propiedades ópticas muy buenas, su superficie de trabajo ofrece el máximo confort de su
categoría gracias a su gran tamaño
• La variedad de dispositivos para objetivos, oculares y otros accesorios a elegir permite su empleo para todos los usos habituales de la microscopia estereoscópica
• Una característica central de esta serie de microscopios variables y, al mismo tiempo, robustos, es que sus elementos mecánicos son muy estables y se ajustan con precisión; se caracterizan por un diseño funcional y ergonómico
• Oculares estándares: HSWF 10 / Ø 23 mm.
www.kern-sohn.com
(Véase anuncio en la sección Guía del Comprador)


AMSBIO
GMP-grade
AMSBIO has launched GMP grade StemFit® for Differentiation - a chemically defined and animal component-free formulation that enables unmatched differentiation of human Induced Pluripotent Stem (hiPS) and Embryonic Stem (hES) cells. This medium now complies with GMP, as required for downstream clinical applications.
The unique chemically defined composition of StemFit® for Differentiation minimizes lot-to-lot variation, enabling highly consistent cell differentiation. The animal-origin free composition minimizes the risk of immunogenic contamination. Manufactured according to strict GMP guidelines, the new gold standard version of StemFit® for Differentiation offers highly reproducible expansion and differentiation of human pluripotent stem cell-derived cells and tissues in clinical manufacturing applications.
Dr. Satoshi Okamoto from the Yokohama City University Graduate School of Medicine said: “Using StemFit® Basic03 for iPSC cell culture with StemFit® for Differentiation, we were able to adopt animal-origin free reagents, which made our culture protocol very stable.”

By the end of 2025, all StemFit® formulations including Basic03, Basic04 CT, and key proteins including bFGF and Activin A, will be available exclusively as GMPgrade formulations. Transitioning the range to GMP grade ensures that every lab using StemFit® can seamlessly move from research to clinical applications without needing to retest materials or change protocols and so reducing complexity and cost.
To keep GMP grade formulations adoption accessible, manufacturing processes have been optimized to minimize the cost difference between research and GMP-grade versions. This ensures that labs can upgrade to GMP without significant financial burden.
Aisha Amari, a stem cell specialist at AMSBIO commented “StemFit® has earned the trust of researchers and biotech companies worldwide, with nearly 1,500 citations and growing adoption in cell and gene therapy”.
To learn more about GMP compliant products and services from AMSBIO please visit https://www.amsbio.com/gmp/gmpproducts-services/. For further information about StemFit® for Differentiation please visit https://www.amsbio.com/stemfitfor-differentiation/ or contact AMSBIO (+31-72-8080244 / +44-1235-828200 / +1-617-945-5033 / info@amsbio.com).

StemFit® for Differentiation in use: Lipid incorporation study in all iPSC-LBs by using DiI-Ac-LDL (Acetylated LowDensity Lipoprotein labeled with 1,1’-dioctadecyl-3,3,3’,3’tetramethylindo-carbocyanine perchlorate). Scale bar, 50 µm. Figure adapted from Sekine, K., Ogawa, S., Tsuzuki, S., Kobayashi, T., Ikeda, K., Nakanishi, N., Takeuchi, K., Kanai, E., Otake, Y., Okamoto, S., Kobayashi, T., Takebe, T., & Taniguchi, H. (2020). Generation of human induced pluripotent stem cellderived liver buds with chemically defined and animal originfree media. Scientific Reports, 10(1). https://doi.org/10.1038/ s41598-020-73908-1
Now part of the Europa Biosite group of companies, AMS Biotechnology (AMSBIO) is recognized as a leading transatlantic company contributing to the acceleration of discovery through the provision of cutting-edge life science technology, products, and services for R&D in the medical, nutrition, cosmetics, and energy industries. AMSBIO has indepth expertise in extracellular matrices to provide elegant solutions for studying cell motility, migration, invasion, and proliferation. This expertise in cell culture and the ECM allows AMSBIO to partner with clients in tailoring cell systems to enhance organoid and spheroid screening outcomes using a variety of 3D culture systems, including organ-on-a-chip microfluidics. For drug discovery research, AMSBIO offers assays, recombinant proteins, and cell lines. Drawing upon a huge and comprehensive biorepository, AMSBIO is widely recognized as a leading provider of high-quality tissue specimens (including custom procurement) from both human and animal tissues. The company provides unique clinical grade products for stem cells and cell therapy applications. This includes GMP cryopreservation technology, and highquality solutions for viral delivery.
www.amsbio.com
Destapador/tapador versátil de un solo tubo que reduce la tensión y optimiza el flujo de trabajo
Diseñado para manipular una amplia gama de tubos de gran formato, incluidos los tubos de centrífuga, de cultivo celular y de muestra de vidrio (11-40 mm), el IntelliXcap™ S1 de Azenta Life Sciences elimina la incomodidad de los ajustes manuales al adaptarse a múltiples tipos de tubos sin necesidad de cambiar la pinza de la tapa. Esta perfecta adaptabilidad ahorra tiempo y simplifica la manipulación de los tubos en laboratorios de bajo a alto rendimiento. Con su diseño ergonómico que se maneja con una sola mano, el IntelliXcap S1 está diseñado para minimizar el riesgo de lesiones por esfuerzo repetitivo, lo que lo convierte en una solución ideal para el uso diario. Su sistema automatizado garantiza la aplicación de un par de torsión constante en cada tapa, lo que proporciona un sellado fiable sin las inconsistencias de la manipulación manual.
Para los laboratorios que actualmente destapan y vuelven a tapar tubos de gran formato a mano, tarea que consume mucho tiempo y es inconsistente, la actualización al IntelliXcap S1 significa un procesamiento más rápido, un mayor rendimiento y una mejor integridad de las muestras, todo en un tamaño compacto que cabe fácilmente en gabinetes de seguridad y espacios de trabajo reducidos.
El contenido tamaño del dispositivo le permite funcionar fácilmente dentro de gabinetes de seguridad y en mesas de trabajo con espacio limitado. Con una excelente relación coste-beneficio, el IntelliXcap S1 ofrece un valor excepcional para los laboratorios que buscan mejorar la productividad y, al mismo tiempo, mantener la integridad de las muestras valiosas. Para obtener más información, visite https://www.azenta.com/products/intellixcap-semi-automated-screw-cap-singletube-decapper-recapper#product-details. Azenta, Inc. provee soluciones para las ciencias biológicas en todo el mundo, que permite comercializar con mayor rapidez avances y terapias de gran impacto. Ofrece un conjunto completo de soluciones fiables de gestión de muestras
de cadena de frío y servicios multiómicos en áreas como el desarrollo de fármacos, la investigación clínica y las terapias celulares avanzadas para las principales instituciones farmacéuticas, biotecnológicas, académicas y sanitarias del sector a escala mundial. Su equipo global ofrece y respalda estos productos y servicios a través de sus marcas líderes en el sector,

entre las que se incluyen Genewiz, FluidX, Ziath, 4titude, Limfinity, Freezer Pro, Barkey y B Medical Systems. Azenta tiene su sede en Burlington, MA, y operaciones en Norteamérica, Europa y Asia.
www.azenta.com

Worldwide first cutting mill with a removable milling chamber
Since April 1st, 2025, the new SM 50 is available for order worldwide, coming along with all the features needed to become a classic in laboratory technology. The development team at Retsch GmbH in Haan, Germany, has successfully developed a compact and powerful cutting mill that comes with a whole series of new benchmarks. The Total Access concept allows access to all relevant components of the grinding process via push-fit. For the first time, even the entire milling chamber can be removed - with just one hand. Retsch CEO Dr. David Szczesny: “With the SM 50, we have developed a powerful and space-saving tabletop cutting mill that raises the process of sample preparation to an entirely new level. Thanks to our unique development approach, we have once more succeeded and reinforced our position as world market leader through our innovative strength.” The basis of all development processes at Retsch is the close and continuous exchange with its customers worldwide. The resulting needs and problems are evaluated and directly integrated into the development process. In addition, Retsch offers free test grinds that provide a valuable exchange with laboratories, companies and scientific institutions from all over the world. Combined with the company’s long-term development expertise, the SM 50 was able to define a new cutting mill that fills a gap in the market.
The Total Access Concept, equipped with an EasyInspect hopper and push-fit components, simplifies the cleaning process for all surfaces, from the hopper to the collection container. For the first time, the removable milling chamber allows cleaning under water. This development represents a true milestone in the field of sample preparation, reducing the entire process time by up to 30% and significantly reducing the risk of sample contamination. The direct integration of the cyclone into the SM 50 represents a groundbreaking technological advancement, enhancing the effectiveness of the system. In combination with an optimal flow dynamic, it achieves an exceptional sample recovery rate up to 100%.
Szczesny: “In addition to grinding performance, we are setting new benchmarks in ergonomics and versatility with the SM 50, which we ensure with our extensive range of accessories. Thanks to the modular design, the grinding chamber and other components can be replaced without tools. I am certain that with the SM 50, we have developed a genuine all-round solution that has been optimally adapted to the different needs of our customers.”
Retsch was founded in 1915 and today, with locations in Germany, USA, China, Japan, India, South Africa, France, Italy, Benelux, Russia, Great Britain and Thailand, is the world’s leading supplier of solutions for comminution and particle measurement technology with an export share of 80 %. Retsch is always looking for customer and market-oriented solutions within the scope of R&D and consistently implements

these in its instruments. Their guiding principles include customer proximity and technological leadership. The result is instruments whose high-quality components interact optimally to guarantee representative and reproducible analysis results with maximum operating convenience and safety. Retsch has been part of the steadily growing international technology group Verder since 1990, where it forms the core of the Scientific Division.
www.retsch.com

Electroválvula 2/2, serie HDI
Las electroválvulas 2/2 de la serie HDI de Lee Company se caracterizan por:
• ser válvulas de dos vías, normalmente cerradas
• usables para líquidos y gases
• fácilmente integrables en el bloque de conexiones.
www.theleeco.com LEE



HANNA INSTRUMENTS
La línea de multiparamétricos portátiles crece con el HI98594
Hanna Instruments presenta el lanzamiento de su innovador medidor multiparamétrico portátil HI98594, una solución diseñada para medir hasta 14 parámetros clave, incluidos el pH, conductividad (CE), oxígeno disuelto (OD) con sonda óptica y, como novedad, la turbidez. Este dispositivo de alto rendimiento destaca por su precisión, durabilidad y facilidad de uso en diversos entornos de trabajo.
- Aplicaciones versátiles
El HI98594 está diseñado para satisfacer las necesidades de diversas aplicaciones en laboratorios y en campo, tales como el monitoreo de aguas residuales, acuicultura, medioambiente, educación y análisis de aguas subterráneas. Su capacidad para medir múltiples parámetros lo convierte en una herramienta esencial para científicos, ingenieros y técnicos en estos sectores.
- Kit completo para un uso profesional
El medidor HI98594 incluye un completo kit de accesorios, todo dentro de un maletín de transporte resistente, que asegura la máxima protección en cualquier entorno. Este kit incluye:
• Sonda multiparamétrica con sensores preinstalados para pH/ORP, conductividad/turbidez y oxígeno disuelto óptico.
• Accesorios de mantenimiento para la protección y cuidado de la sonda, incluidos un protector de sonda y un kit de mantenimiento.
• Soluciones de calibración Quick-CAL para pH y conductividad, solución de oxígeno disuelto cero y soluciones para la calibración de turbidez.
• Funda protectora de goma para mayor durabilidad y protección.
- Calibración rápida y precisa
La calibración del HI98594 es sencilla y rápida, con un sistema de calibración de un solo punto para pH, conductividad y oxígeno disuelto, lo que facilita su uso en campo. Su diseño compacto asegura una portabilidad excepcional y una operación cómoda, incluso en condiciones de trabajo exigentes.
- Resistencia y durabilidad en condiciones extremas
El medidor HI98594 está construido para resistir condiciones ambientales severas. Con un grado de protección IP67 (inmersión a 1 m durante 30 minutos) y una sonda multisensorial sellada con IP68 (inmersión continua en agua), el HI98594 ofrece una fiabilidad excepcional, incluso en ambientes extremos. Equipado con una doble fuente de alimentación, dispone de una batería interna de litio recargable, que cuando está completamente descargada, el medidor cambia a las baterías alcalinas de respaldo para evitar paradas inesperadas.
- Registro de datos y conectividad avanzada
El HI98594 permite registrar datos de forma continua o en puntos específicos, con la posibilidad de almacenar los regis-
tros en lotes nombrados y añadir comentarios. Gracias a su conectividad Bluetooth y la aplicación Hanna Lab, los datos registrados pueden transferirse fácilmente a dispositivos móviles para su análisis y envío por correo electrónico. Además, el medidor recibe actualizaciones automáticas de firmware a través de la app Hanna Lab, lo que garantiza un funcionamiento siempre optimizado.
- Muestreo de bajo caudal
La célula de flujo es un accesorio esencial para realizar mediciones continuas de parámetros como pH, conductividad, oxígeno disuelto y turbidez. Garantiza un flujo uniforme de la muestra, optimizando el contacto entre los sensores y el líquido y reduciendo las interferencias externas. Esto permite obtener mediciones estables y precisas a lo largo del tiempo. Es el complemento perfecto para el monitoreo y muestreo en campo, incluyendo pozos de aguas subterráneas.
- Parte de la innovadora Serie 98 de Hanna Instruments
El HI98594 se integra perfectamente en la serie de medidores multiparamétricos portátiles Serie 98 de la firma, diseñada para ofrecer soluciones precisas y fiables en una variedad de aplicaciones de laboratorio y de campo.
Para más información sobre la familia de medidores multiparamétricos de Hanna Instruments, visita www.hanna.es o contacta con el equipo de atención al cliente en info@hanna.es.
www.hanna.es
(Véase anuncio en la sección Guía del Comprador.)

With its green limited edition, Julabo brings color into your daily laboratory routine

For a short campaign period, Julabo is making sustainability visible for the laboratory: on request and at no extra charge, you can order selected models of their new energy-efficient refrigerated circulators as a special green edition until 30 June 2025.
From the Green Edition, you can choose from various Corio CD, Corio CP, Dyneo DD and Magio MS models. All cooling capacities between 310 W and 1.25 kW are available. With units from this Limited Edition, you are not only showing your colors: with our new refrigerated circulators, you are opting for a sustainable and future-proof solution without compromising on precision and performance/output.
As a future-oriented manufacturer, Julabo consistently ensures the insertion of natural and therefore environmentally friendly refrigerants in all new product developments. Last year, they switched all refrigerated circulators to natural refrigerants.
In addition to the insert of natural refrigerants, the ecological footprint of their temperature control instruments also includes their operation by the customers. With the latest generation of refrigerated circulators, Julabo is setting standards in the range of energy efficiency. Units with cooling capacities from 800 W can reduce power consumption in many temperature control applications in the partial load range by until 70%. This not only reduces operating costs but also makes a positive contribution to climate protection.
Would you like your refrigerated circulator as a special green edition? Select your desired device in the product overview and check the box for the “Green Your Lab Limited Edition” product option - or contact your Julabo specialist dealer.
www.julabo.es
(Véase anuncio en la sección Guía del Comprador.)

Cámara climática EICS HR: métodos gravimétricos
Testing Lab Equipments es especialista en ofrecer soluciones avanzadas para el análisis y ensayo en el ámbito de la calidad del aire. Aquí presenta el desarrollo y fabricación de una cámara climática diseñada específicamente para cumplir con los exigentes requisitos de las normas que regulan la determinación de la concentración másica de partículas en suspensión PM10 y PM2.5 en el aire ambiente.
- Cuarto o cabina de pesadas
Las normativas para el seguimiento de las concentraciones másicas de la materia particulada en suspensión (PM10 y PM2,5) en aire ambiente, relativas a la calidad del aire ambiente, establecen parámetros específicos para la evaluación de los niveles de la concentración
INFRICO MEDCARE
ambiental de la materia particulada. Las pesadas realizadas deben realizarse en unas condiciones determinadas de temperatura y humedad, donde se colocarán las balanzas. Las cámaras EICS HR proporcionan condiciones de alta estabilidad y uniformidad.
- Control de temperatura y humedad Control preciso de las condiciones de temperatura y humedad, fundamentales para asegurar la fiabilidad de las mediciones y la exactitud de los resultados. Tecnología de calefacción dual y calentadores eléctricos de acero inoxidable. La humidificación se realiza mediante un sistema de ultrasonidos que no aporta calor al medio generando gotas microscópicas en el interior de la cámara.
Armario de ultracongelación bajo encimera
Infrico MedCare presenta el ULT11086, armario de ultracongelación (de -40 a -86 ºC) bajo encimera de 125 l de capacidad. Entre sus características destacan:
• Controlador Digital Plus con pantalla táctil de 5″ y batería para asegurar el registro de alarmas y temperatura.
• Puerto USB para descarga de datos y puerto modbus RS485.
• Interior de acero inoxidable, dos puertas interiores y puerta sólida con cierre ergonómico.
• Incorpora un estante de acero inoxidable y dos pasamuros.
Con la seguridad como objetivo principal, esta gama de congeladores de ultrabaja temperatura pretende satisfacer las necesidades más exigentes asegurando un almacenamiento duradero y fiable de las muestras más sensibles.
La gama de congeladores a la que pertenece este modelo consta de diferentes propuestas con volúmenes que van desde los 110 a los 800 l, siempre en el intervalo de temperatura de -40 a -86 °C. Otras singularidades de estos equipos:
• Hasta cuatro niveles de almacenamiento para más de 50.000 microtubos.
• Controlador Digital Plus con pantalla TFT táctil de 5 pulgadas fácil e intuitiva (opcional 7 pulgadas)
• Refrigerantes naturales y biodegradables, libres de CFC y HCFC respetuosos con el medioambiente
• Batería para mantener el registro de temperatura y alarmas hasta 48 horas en caso de fallo de alimentación
• Salida USB integrada en el controlador para una fácil y rápida descarga de datos
• Puertas interiores, estantes y recubrimiento interior de acero inoxidable
• Sistema de doble circuito frigorífico (excepto ULF11086)
• Máximo aislamiento y reducción de consumo de energía con óptimo aprovechamiento del espacio útil
• Cierre ergonómico de gran robustez y fiabilidad
• Apertura de 180º de puerta
• Registro y alta precisión en el control de temperaturas y alarmas.
En el caso de los congeladores tradiciona-
- Flujo de aire
Sistema optimizado de aire para generar las condiciones climáticas más estables y uniformes. Un flujo de aire horizontal (EICHS) introduce el aire tratado por ambas paredes perforadas de la cámara, siendo absorbido centralmente en la base de la cámara, creando una corriente horizontal y descendente en todos los estantes presentes en el equipo de flujo suave de aire para evitar fluctuaciones en las medidas.
- Estante telescópico reforzado
El diseño del equipo se basa en una bandeja reforzada posicionada en la parte inferior de la cámara, una bandeja sólida que evita la transmisión de las posibles vibraciones que se den en

les, el funcionamiento del ultracongelador depende de un solo compresor. Si falla este, la temperatura del equipo desciende bruscamente hasta la temperatura ambiente. En cambio, los ultracongeladores ULF MedCare están dotados de un sistema de doble circuito frigorífico independiente con compresor con bajo nivel de ruido. En caso de fallo de uno de ellos, el otro es capaz de mantener la temperatura del equipo a -70 °C. Los equipos de Infrico MedCare están equipados con compresores fiables de gran potencia, capaces de dar una rápida respuesta tras aperturas de puerta para la recuperación de la temperatura. Para mayor seguridad de las muestras, los ultracongeladores pueden dotarse de sistemas de respaldo de CO2
www.infricomedcare.com
(Véase anuncio en la sección Guía del Comprador.)
novedades
la cámara a la balanza de precisión dentro de la cámara.
El estante es de acero perforado inoxidable AISI 304, con una carga máxima de 100 kg/m2
- Puerta interior de cristal
La serie EIC incorpora una puerta interior de cristal térmico que permite visualizar los procesos de trabajo sin alterar ni temperatura, ni/o la humedad. La puerta lleva un cierre con burlete de silicona para asegurar una estanquidad máxima y un tirador y cierre de gran tamaño.
En el cristal se pueden situar guantes para manipulación de las muestras sin necesidad de abrir la puerta interior ni alternar las condiciones interiores.
Controlador de la serie 4500: controlador intuitivo y sencillo con pantalla gráfica de 7” en color, basado en microprocesador, con visualización de la temperatura y la humedad real en cada momento.
Registrador de datos integrado, con lecturas cada 15 s, permite lecturas de hasta 30 días. Incorpora un puerto USB para la descarga de los datos registrados.
Las principales ventajas del equipo son, en resumen:
· 15 volúmenes diferentes
· Intervalo de temperatura: de +10 a +50 °C
· Interavlo, de humedad: de 40% a 80% HR

· Flujo de aire horizontal
· Alta uniformidad y estabilidad
Refrigeración basada en sistema mecánico con gases de bajo GWP (3)
· Interiores de acero inoxidable, redondeados para su fácil limpieza
· Puerta interior de cristal
· Guantes para manipulación de las muestras
· Control basado en pantalla táctil a color de 7”.
www.testinglab.es

Herramienta preparada para auditorías para la validación de bombas HPLC
Testa Analytical ha lanzado una versión actualizada de su paquete de calificación de bombas HPLC diseñado para laboratorios regulados que buscan calificar el funcionamiento y el rendimiento de sus sistemas HPLC.
La versión 1.4 del popular paquete de calificación de bombas HPLC incluye actualizaciones que hacen que la herramienta sea más flexible y esté preparada para auditorías.
Las mejoras incluyen una nueva lista de verificación de validación de bombas para guiar a los usuarios a través del proceso de validación paso a paso, lo que garantiza un flujo de trabajo estructurado y reduce así la posibilidad de errores. Los usuarios pueden ahora ajustar los límites de aceptación de precisión del 0,5 al 5% (la norma de la EDQM, Dirección Europea de Calidad de Medicamentos y Asistencia Sanitaria). Esta nueva flexibilidad permite a los usuarios alinearse con varias normas regulatorias y especificaciones de bombas. Los criterios de aprobación de la calificación de bombas HPLC ahora consideran tanto
la desviación estándar relativa como la desviación nominal, de acuerdo con las pautas de la EDQM.
El paquete de calificación de bombas HPLC incluye un caudalímetro LC Testa Analytical, una tableta con software de validación de datos preinstalado. El paquete está diseñado para realizar automáticamente todos los cálculos de datos de flujo necesarios, además de controles de calificación operacional y de rendimiento en su sistema HPLC. Esta versión actualizada del paquete reduce el tiempo necesario para la calificación de bombas HPLC, al tiempo que proporciona resultados trazables y listos para auditoría. Al centrarse en la trazabilidad de los datos y simplificar el proceso de calificación, este paquete todo en uno listo para auditoría es una solución asequible para los laboratorios que buscan mantener el cumplimiento y optimizar sus sistemas HPLC de manera rápida y eficaz.
Para obtener más información, visite https://testa-analytical.com/hplc-pumpqualification-pack.html o comuníquese

El informe de calificación del rendimiento de HPLC se obtiene en 10 minutos
con Testa Analytical (+49-30-864-24076 / info@testa-analytical.com).
Testa Analytical Solutions es un proveedor líder especializado en instrumentos y detectores de cromatografía líquida. Con más de 30 años de experiencia, se ha establecido como un respetado creador y proveedor de kits de instrumentos y detectores de cromatografía líquida de alto rendimiento, innovadores y de primera calidad para usuarios finales y clientes OEM en todo el mundo.
www.testa-analytical.com

novedades
Pipetas Acura® manual: máximo confort en tu trabajo
La ergonomía es el principio fundamental en la línea de pipetas Acura® manual. Desde la superficie suave y elástica de la carcasa hasta la acción suave del émbolo, cada detalle ha sido diseñado para ofrecer un confort superior y un pipeteado sin esfuerzo. Los resortes de baja resistencia y el anillo hermético con una funda de PTFE minimizan la fricción del émbolo. Además, la amplia superficie del botón de expulsión permite una activación con mínima presión. El sistema de ajuste de la altura del vástago Justip™ facilita el uso de una amplia gama de puntas, asegurando un ajuste perfecto en el cono.
Las pipetas Acura® manual están fabricadas según las normas nacionales e internacionales de calidad. Cada instru-
mento cuenta con un número de serie único y pasa por un riguroso control, que se documenta a través de un certificado de control de calidad individual. Además, vienen con una garantía de tres años.
Socorex ofrece paquetes de pipetas a precios competitivos. El Triopack™ es un kit práctico y listo para usar que incluye tres pipetas Acura® manual, muestras de puntas Qualitix®, certificado de control de calidad y manual de instrucciones. Está disponible en nueve combinaciones, cubriendo volúmenes desde 0,1 µl hasta 10 ml, ideales para aplicaciones que van desde la genética molecular hasta el análisis ambiental. Existen opciones que se ajustan perfectamente a las diversas necesidades del laboratorio.

www.socorex.com/es
(Véase anuncio en la sección Guía del Comprador.)

Derek Thomas Azenta Life Sciences
Hacia un nuevo ‘estándar de oro’ para el procesamiento de placas.
Las placas y microplacas de PCR suelen requerir algún tipo de sellado para evitar la evaporación, que, de lo contrario, podría alterar las concentraciones de la muestra y afectar a la reproducibilidad. El sellado y el despegado manual de las placas puede ser un proceso económico para laboratorios y flujos de trabajo de bajo volumen; sin embargo, a medida que aumenta el volumen, crece el riesgo de peligros y limitaciones asociados. Estos pueden incluir:
Lesión por esfuerzo repetitivo
El tiempo de ausencias de la fuerza laboral por lesiones puede tener una clara relación con el rendimiento del laboratorio y potencialmente aumentar las cargas de trabajo ya de por sí elevadas. Una causa común en las ausencias por enfermedad es el síndrome del túnel carpiano (STC),

que ha experimentado un aumento del 500% en las últimas dos décadas, lo que provoca más días de trabajo perdidos que cualquier otra lesión laboral1. Las condiciones de trabajo y el tipo de trabajo se han establecido como más importantes que las características físicas para determinar la gravedad de la neurocompresión, y el regreso al trabajo está más fuertemente influenciado por las condiciones
de trabajo que por los factores clínicos o las características físicas1,3,4
Los usos ocupacionales de las manos que se consideran factores de riesgo ergonómico incluyen movimientos de muñeca muy repetitivos y una gran fuerza de pinza, como al sellar y pelar placas. La repetición es el factor de riesgo más reconocido y se define por la frecuencia
de la tarea o la proporción de tiempo dedicado al trabajo repetitivo.
Los estudios epidemiológicos también han considerado la fuerza elevada de agarre en la mano o los dedos como un factor de riesgo para el síndrome del túnel carpiano, según el peso de la herramienta utilizada o el impacto.
Contaminación cruzada y evaporación
Independientemente del nivel de capacitación o atención, pueden ocurrir errores humanos, o al menos presentar cierto grado de inconsistencia. En cuanto al sellado manual, los riesgos pueden provenir de diversas fuentes, entre ellas:
- Uniformidad del sello a lo largo de la placa: si no se aplica una presión uniforme a un sello adhesivo con la fuerza adecuada, esto puede provocar que los pozos queden mal sellados o sin sellar, lo que puede provocar la evaporación de reactivos costosos o incluso el movimiento de la muestra de un pozo a otro.
- Sellado excesivo de pozos: en los casos en que se haya aplicado demasiada fuerza al sello, puede causar problemas de desprendimiento más adelante en el proceso.
- Métodos de termosellado no probados: En los casos en que se han establecido soluciones “hechas en casa” para este proceso, pueden presentarse problemas de temperatura o tiempo de sellado inconsistentes, lo que resulta en sellos dañados o pozos mal sellados. Esto también puede provocar contaminación cruzada entre pozos o la evaporación de la muestra y el reactivo.
Los métodos de despegado manual también pueden ser igualmente riesgosos y presentar peligros como:
- Mal manejo accidental: puede ocurrir contaminación cruzada por el mal manejo accidental de las placas durante el despegado; si la placa o el sello resba-
lan durante el despegado, las muestras pueden verse obligadas a traspasar de un pozo a otro, lo que hace que toda la placa quede inutilizable.
- Escurrimiento de la muestra: dependiendo del ángulo de extracción del sello, es posible que la muestra pegada a la parte inferior del sello, debido a la tensión superficial, se “escurra” por el sello y entre en otro pozo, lo que provoca contaminación cruzada.
Tiempo perdido por cuellos de botella
En muchos laboratorios, el despegado y resellado manual puede consumir cientos de valiosas horas de trabajo en tan solo unas pocas semanas de trabajo. En cualquier organización donde la alta productividad sea crucial -por ejemplo, una operación competitiva de descubrimiento de fármacos-, los retrasos debidos a este cuello de botella pueden suponer graves contratiempos para los objetivos del laboratorio, o incluso para los planes de negocio generales.
Además, la extracción manual de sellos suele obligar a una asignación inadecuada de recursos humanos, y la costosa automatización no se aprovecha al máximo. El tiempo dedicado a retirar sellos y volver a sellar manualmente las placas impide que los técnicos se ocupen de proyectos más importantes para el avance científico3
SELLADO
Contaminación cruzada
RSI
Inconsistencias
Evaporación
ENSAYO
Cuello de botellaproceso de ralentización
Rendimiento limitado
Reproducibilidad
El impacto de la evaporación de reactivos y la pérdida de muestras puede ser drástico al realizar experimentos de alto rendimiento, mientras que la contaminación cruzada de placas debida a errores humanos también afecta a los recursos del laboratorio. Ambos factores requieren la repetición de ensayos y aumentan el coste total de los reactivos.
Especificaciones de las instalaciones
Al elegir un equipo de sellado/despegado de placas, es importante considerar las especificaciones de su laboratorio. Por ejemplo, algunos modelos de selladoras de placas requieren una línea de aire externa. Adaptar los laboratorios existentes para incorporar una línea de aire externa puede ser costoso, y más aún si se considera el tiempo de parada requerida para hacer esta adaptación. La selladora de placas queda fijada a una ubicación y no se puede mover fácilmente a menos que también se adapten las líneas de aire externas.
La altura de la mesa o plataforma también puede ser un factor limitante; con muchos sistemas de automatización con alturas de plataforma bajas, las restricciones de altura pueden ser un factor limitante.

ALMACENAJE
Contaminación cruzada
Inconsistencias
EvaporaciónCoste del reactivo
DESPEGADO DE SELLO
Contaminación cruzada
Inconsistencias
EvaporaciónCoste del reactivo
Cuello de botella: Degradación de la muestra Tiempo / Eficiencia
Automatización para superar los riesgos del sellado y pelado manual de placas
Al buscar una solución que le ayude a alcanzar el estándar de excelencia en sellado y despegado, es importante considerar los problemas planteados. La automatización desempeña un papel claro en la mitigación de los riesgos asociados con los peligros y limitaciones identificados, como se detalla en la infografía de la derecha. Una solución de Azenta Life Sciences combina la selladora térmica de rollos automatizada y el removedor automático de sellos de placa para ayudarle a superar las preocupaciones, desde la contaminación cruzada hasta los requisitos de las instalaciones, como lo demuestra el Dr. Vlad Zarayskiy, científico principal, en el caso práctico que acompaña a este documento5
Lesión por esfuerzo repetitivo
Reducir los pasos mecánicos que requieren los técnicos, al eliminar la necesidad de añadir y remover manual y repetitivamente los sellos de placa, tiene un claro beneficio en la reducción del riesgo de lesiones por esfuerzo repetitivo (LER). La selladora térmica de rollos automatizada, por ejemplo, puede realizar hasta 5.000 sellos sin intervención manual.
Contaminación cruzada y evaporación
La automatización permite un control de calidad óptimo a través del sellado seguro y uniforme de las placas, lo que minimiza la evaporación de reactivos valiosos y el riesgo de contaminación cruzada, mientras que el despegado preciso y automatizado mediante el removedor de sellos de placa automático reduce aún más el riesgo de contaminación cruzada por el escurrimiento de la muestra.
Tiempo perdido por cuellos de botella
La automatización de los pasos de sellado y despegado de sellos de placas agiliza el procesamiento de estas y ayuda a los la-
Sellado uniforme y consistente para proteger contra la contaminación
Elimina el sellado manual y el riesgo asociado de RSI
Los sellos seguros minimizan la evaporación de reactivos costosos
ENSAYO
Procesos más rápidos > mayor rendimiento
Las placas selladas de forma segura reducen el riesgo de contaminación cruzada durante el almacenamiento

Rendimiento escalable
Mayor reproducibilidad debido a una mayor integridad de la muestra
boratorios a aumentar la productividad, a la vez que libera tiempo a los científicos. La integración en flujos de trabajo robóticos mejora aún más el flujo de trabajo, proporcionando un sistema autónomo.
Coste
El sellado térmico automatizado de placas proporciona una reducción de costes en comparación con otros métodos de sellado, como tapas o sellos adhesivos, mientras que una mayor preservación de la integridad de la muestra al minimizar la contaminación cruzada y la evaporación significa que se ahorrarán muestras y reactivos valiosos.
Especificaciones de las instalaciones
Al eliminar el requisito de aire comprimido, el sellador térmico de rollo automatizado se puede instalar rápidamente y tiene la flexibilidad de moverse dentro del laboratorio, ya sea como una unidad de sobremesa independiente o una configuración robótica integrada, independientemente del suministro de aire.
Ahorro en el coste del reactivo gracias a la minimización de la evaporación durante el almacenamiento
El pelado preciso y automatizado minimiza el riesgo de contaminación cruzada Las especificaciones exigentes garantizan la consistencia La eliminación del cuello de botella manual protege contra la degradación de la muestra al reducir el tiempo que permanece en la mesa de trabajo. Los procesos más rápidos permiten un mayor rendimiento Proceso Walkaway: rendimiento confiable y consistente
1. Kao, YS. (2003) “Carpel Tunnel Syndrome as an Occupational Disease”, JABFP, 16, (6), pp 533-542.
2. Moore, JS., Garg, A. (1994) “Upper extremity disorders in a pork processing plant: relationships between job risk factors and morbidity”, Am Ind Hyg Ass, 55, pp 703-715.
3. De Kesel, R., Donceel, P., De Smet, L. (2008). “Factors influencing return to work after surgical treatment for carpel tunnel syndrome”, Occupational Medicine, 58, pp187-190.
4. Shiri, R., Miranda, H., Heliovaara, M., Viikari-Juntura, E. (2009), “Physical workload factors and carpel tunnel syndrome: a population-based study,” Occup Environ Med, 66, pp 368-373.
5. The Transformative Benefits of Automation in High Throughput Drug Discovery Workflows. Azenta Life Sciences White Paper (2019). https:// www. azenta.com/resources/transformativebenefits-automation-high-throughput-drug-discovery-workflows
www.azenta.com


Sra. Morant, su currículum nos dice que es usted ingeniera, ergo científica. ¿Cree que la empresa y la ciencia son en España lo suficientemente simbióticas? Si no, ¿qué iniciativas ha adoptado o adoptará el ministerio para mejorar esta situación?
En el Gobierno de España estamos trabajando para mejorar y aumentar la colaboración entre el sistema empresarial y el sistema público de ciencia para que los resultados de la investigación se transfieran de manera más eficiente desde las instituciones científicas que los generan hacia las empresas que los transforman en nuevos productos y servicios, con impacto económico y social.
En el Gobierno de España estamos trabajando para mejorar y aumentar la colaboración entre el sistema empresarial y el sistema público de ciencia
Desde el ministerio de Ciencia, Innovación y Universidades estamos poniendo el foco en reformas regulatorias y nuevos instrumentos de apoyo que faciliten la transferencia de conocimiento entre las universidades y centros de investigación y las empresas. Dos ejemplos son la Reforma de la Ley de la Ciencia que aprobamos en 2022 o el Plan de Transferencia de Conocimiento y Colaboración.
Estamos introduciendo nuevos incentivos y regulaciones más flexibles para que el personal investigador colabore con el sector privado. También estamos aumentando las ayudas a proyectos de I+D colaborativos entre empresas y centros públicos de investigación, así como el apoyo y la financiación al emprendimiento científico.
¿Cuándo cree que España puede alcanzar –si no superar, por qué no– el nivel medio de la Unión Europea en cuanto a inversión en I+D+i? ¿En qué áreas de la actividad valora su ministerio que este desfase es más acusado?
Estamos en cifras récord de inversión en I+D: más de 22.300 millones de EUR en 2023 (último dato disponible), lo que representa un 1,49% del PIB. Cuando llegamos al Gobierno en 2018 estaba en el 1,23%. En términos absolutos, desde 2018, el gasto en I+D en España ha crecido un 50%. Al verlo como porcentaje del PIB no se aprecia tanto el aumento, porque el PIB también ha crecido mucho en ese periodo.
Estamos logrando grandes avances. En 2023 el crecimiento anual de la inversión en I+D fue del 16%; más del doble que la media de la UE (6,5%). Hemos subido dos posiciones en el ranking europeo de innovación. Y somos el segundo país de la UE que más fondos del Plan de Recuperación ha dedicado a la ciencia y la innovación. Es un importante progreso que hay que reconocer, pero todavía nos queda recorrido para alcanzar la media de la Unión Europea.


Por el futuro de nuestro país, no podemos bajar el ritmo. Es difícil concretar cuándo alcanzaremos el nivel medio de la UE, porque no solo depende de nosotros. También depende del compromiso de las comunidades autónomas. Y, sobre todo, depende de que las empresas españolas aumenten su gasto en I+D hasta alcanzar los estándares europeos.
En España el sector empresarial ejecuta el 56,4% del gasto en I+D, diez puntos por debajo de la media de UE (66,8%). Por eso, para nosotros es prioritario impulsar la I+D en nuestras empresas.
¿Cómo ve el nivel científico y técnico de la población española en general?
Según el último Eurobarómetro, España está más o menos en la media de la UE en cuanto a conocimientos sobre hechos científicos o incluso por delante en algunos temas, aunque por supuesto hay margen de mejora.
Es importante que la gente comprenda no solo los hechos, sino cómo funciona la ciencia e impacta en sus vidas. En este sentido, tanto la educación como la comunicación social de la ciencia son fundamentales. Por ejemplo, en la Encuesta de Percepción Social de la Ciencia que elabora FECYT vimos que, tras la pandemia, la comprensión sobre cómo probar la eficacia de un fármaco aumentó del 32,7% en 2020 al 45,3% en 2022, lo que podría deberse al aumento de información sobre estas cuestiones durante la pandemia de la covid-19.
Es difícil concretar cuándo alcanzaremos el nivel medio de la UE, porque no solo depende de nosotros. También depende del compromiso de las comunidades autónomas
Otro dato interesante es la confianza en los científicos. La mayoría social confía en sus científicos y científicas. También la última encuesta de FECYT refleja que 8 de cada 10 personas creen que los métodos de investigación son la mejor manera de averiguar si algo es verdadero o falso. Frente a la desinformación, la sociedad se alimenta de ciencia y de conocimiento. Queremos un país que progrese de la mano de la ciencia, un país donde la sociedad integre el conocimiento científico en su cultura, en su día a día.
Nacida en Gandía (Valencia) en 1980.
Formación académica:
Ingeniera de Telecomunicación por la Universidad Politécnica de Valencia
Trayectoria política y profesional:
Ministra de Ciencia, Innovación y Universidades (noviembre 2023 - actualidad)
Ministra de Ciencia e Innovación (julio 2021 - noviembre 2023)
Alcaldesa de Gandía (2015 - julio 2021)
Miembro del Consejo de Administración de la Autoridad Portuaria de Valencia (enero 2020 - julio 2021)
Miembro del Consejo Territorial de la Federación Española de Municipios y Provincias (septiembre 2019 - actualidad)
· Vocal del órgano decisorio de la Spain Convention Bureau (junio 2016 - mayo 2019)
Miembro del Consell de Turisme de la Generalitat Valenciana (junio 2015 - septiembre 2021)
Diputada en la Diputación Provincial de Valencia (julio 2015 - mayo 2017)
Concejala en el Ayuntamiento de Gandía (2011-2015)

Técnicas de Laboratorio alcanza con esta edición su número 500 y hemos creído oportuno invitar a este aniversario a varias empresas que han estado y están al lado de una publicación que es testimonio histórico de los cambios espectaculares (aquí hay unanimidad) registrados en el mundo de los análisis y la medición. Esperamos que estas compañías y la revista vean por lo menos 500 ediciones más.
Desde 1969, el sector del análisis ha experimentado grandes avances en tecnología, metodologías y normativa. ¿Cuáles consideran que han sido los principales cambios que han transformado el sector del análisis desde entonces y cómo han influido en la calidad y precisión de los resultados?

AVANTOR SPAIN
José Luis Portillo, Sales and Managing Director
1. Desde 1969, nuevas tecnologías instrumentales han sin duda influido en la calidad de los resultados analíticos, como por ejemplo la incorporación extensiva de la cromatografía liquida de alta resolución, y de la espectrometría de masas, entre muchas otras. Y mientras nuevas tecnologías se han ido incorporando, la progresiva e imparable automatización de los flujos de trabajo ha empezado a transformar pro-
El sector del análisis afronta continuamente nuevos retos en cuanto a regulación, innovación y sostenibilidad. ¿Cuáles creen que han sido los mayores desafíos para las empresas del sector durante estos años y cómo se han adaptado a las tendencias cambiantes del mercado?
¿Qué previsiones tienen para el sector del análisis y la evolución de las tecnologías, y qué innovaciones creen que marcarán el sector en los próximos 10 o 20 años? 1 2 3
fundamente los laboratorios, aumentado la eficiencia, precisión y exactitud en los procesos o resultados. Además, el sector también ha experimentado grandes avances en la rigurosidad de validación de los métodos analíticos con la implementación de estándares internacionales como ISO y GLP. Estas regulaciones más estrictas han obligado a los laboratorios a mantener altos niveles de calidad y han aumentado la confianza en los resultados obtenidos. Y todo ello con la irrupción progresiva y definitiva durante estas últimas 5 décadas de la digitalización, también en los laboratorios, y la consecuente adopción de herramientas y tecnologías digitales: del papel al ordenador. En conjunto, todos estos cambios han transformado la calidad y precisión de los resultados analíticos en estas últimas décadas.
2. Efectivamente, las empresas del sector del análisis se han enfrentado a desafíos
importantes en regulación, innovación y sostenibilidad. Adaptarse a regulaciones cada vez más estrictas ha requerido inversión en sistemas de calidad y formación continua. Por otro lado, la rápida evolución tecnológica también ha obligado a estos esfuerzos en inversión y formación. Además, un continuo aumento en los compromisos sociales corporativos en adoptar prácticas sostenibles ha llevado a implementar procesos más ecológicos.
3. Desafíos como eficiencia, productividad, sostenibilidad y más regulación continuarán estando presentes durante los próximos años en el sector. Nuevas tecnológías se irán incorporando, pero sobre todo una mayor necesidad de su automatización, alcanzando a todo el flujo de trabajo. Además, delante de la necesidad de ser más productivos (más resultados con los mismos o menos recursos humanos), podría acelerarse la aún discreta subcontratación especiali-

zada de tareas técnicas que cada laboratorio considera que no son estratégicas (“non core”), para concentrar sus recursos en las que sí lo son. Además, la optimización del proceso de aprovisionamiento de materiales y servicios científicos requerirá más la atención de los laboratorios. Y sin duda alguna, la adoptación de herramientas de inteligencia artificial en algunos procesos de su producción de resultados analíticos. En este sentido, se espera que la inteligencia artificial generativa se integre cada vez más en plataformas de análisis. Todos estos aspectos, entre otros, serán imprescindibles para mantener la capacidad y competitividad de los laboratorios.

CALIBRE SCIENTIFIC
Miguel Ángel Rubio Alonso, Product manager
1. En estos más de 50 años transcurridos desde el 1969, las mejoras y avances en los sistemas de toma de muestra, en los ataques de las mismas y el desarrollo en tecnología de precisión de los equipos de análisis, sea cromatografía, ICP, absorción atómica… ha hecho que se mejorara en varios ordenes de magnitud en el análisis cuantitativo y, respecto al cualitativo, mejorar los tiempos también.
2. El estar al día en las normativas que han ido saliendo y poder cumplirlas dando resultados efectivos.
3. Imagino que además de seguir mejorando y perfeccionando las técnicas, mejorar los tiempos de análisis y el tratamiento de los datos.

FISHER SCIENTIFIC
Ángel Barroso, director Europeo de Aplicaciones
1. Desde 1969, el sector del análisis ha experimentado avances significativos en tecnología, metodologías y normativa que han mejorado la calidad y precisión de los resultados. Los principales cambios incluyen la evolución de instrumentación analítica avanzada, la digitalización y automatización de procesos y el desarrollo de nuevas metodologías como la resonancia magnética nuclear y la espectrometría de masas. Además, la implementación de estándares internacionales y Buenas Prácticas de Laboratorio (GLP) ha estandarizado los procedimientos, asegurando la reproducibilidad y fiabilidad de los datos.
Thermo Fisher Scientific ha sido un actor clave en estos avances, desarrollando instrumentos analíticos de vanguardia y ofreciendo soluciones integradas que incluyen software, reactivos y servicios de soporte. Su inversión en I+D, junto con programas de capacitación y soporte técnico, ha facilitado la implementación de tecnologías avanzadas en laboratorios, contribuyendo significativamente a la precisión y calidad de los análisis en el sector.
2. El sector del análisis ha enfrentado importantes desafíos en estos tres ámbitos. Las empresas deben cumplir con normativas cada vez más estrictas y complejas, lo que ha llevado a inversiones en sistemas de gestión de calidad robustos y la adopción de estándares internacionales como la ISO 17025 para acreditación de los laboratorios. Además, la rápida evolución tecnológica exige una constante innovación, impulsando a las empresas a incrementar su inversión en
I+D y a adoptar tecnologías emergentes como la inteligencia artificial (IA). Para abordar la sostenibilidad, las empresas están implementando prácticas que reducen el impacto ambiental, como el uso de energía renovable y la gestión eficiente de residuos. Además, han adoptado políticas de responsabilidad social corporativa (RSC) que promueven la sostenibilidad en toda la cadena de suministro.
En respuesta a las tendencias del mercado, las empresas han avanzado en la digitalización y automatización para mejorar la eficiencia y precisión de los análisis. También han formado alianzas estratégicas y colaboraciones para compartir conocimientos y recursos, y han centrado sus esfuerzos en satisfacer mejor las necesidades de sus clientes ofreciendo soluciones personalizadas y servicios de valor añadido. Estas estrategias han permitido a las empresas mantenerse competitivas y adaptarse eficazmente a un entorno en constante cambio.
Thermo Fisher está afrontando los desafíos del sector del análisis mediante una estricta adherencia a normativas internacionales y la implementación de sistemas de gestión de calidad, junto con una inversión significativa en I+D para integrar tecnologías avanzadas como la IA y la automatización. Además, está adoptando un creciente número de prácticas sostenibles, desarrollando productos ecológicos y promoviendo la responsabilidad social corporativa para minimizar su impacto ambiental, asegurando así su liderazgo y competitividad en un entorno regulatorio y tecnológico en constante evolución.
3. En Thermo Fisher prevemos que el sector del análisis experimentará una creciente digitalización y automatización, con tecnologías como la IA y el aprendizaje automático optimizando el procesamiento de datos y la toma de decisiones. Además, se espera un aumento en el desarrollo de dispositivos portátiles y tecnologías de análisis en tiempo real, permitiendo obtener resultados inmediatos en el campo o en entornos clínicos.
La medicina de precisión y los análisis personalizados serán áreas de gran creci-
miento, impulsadas por avances en la secuenciación de nueva generación (NGS) y otras técnicas de biología molecular. La sostenibilidad también será un foco clave, con énfasis en la reducción del impacto ambiental a través del desarrollo de reactivos y consumibles ecológicos, y la implementación de prácticas de economía circular para minimizar residuos. Innovaciones como las tecnologías ómicas, la nanotecnología y la creación de laboratorios autónomos transformarán significativamente el sector. La integración de datos y la conectividad facilitarán la colaboración global y el intercambio de información. En conjunto, estas tendencias y tecnologías avanzadas mejorarán la precisión, eficiencia y sostenibilidad de los procesos analíticos en los próximos 10 a 20 años.

Miren Elexpuru, gerente
1. En lo referido a los sectores preferentes de la actividad de Hanna instruments, esto es, la fabricación de instrumentos para el control y análisis de aguas y alimentación, los avances han sido enormes, empezando por los instrumentos eléctricos con indicadores de aguja, para pasar a la tecnología analógica con pantallas digitales, para evolucionar posteriormente a la era de la digitalización microelectrónica, en la captura automática y análisis de datos en tiempo real, tanto en instrumentos de laboratorio como de proceso.
2. En cuanto a la normativa, es claro que en tantos años ha cambiado y más aún desde nuestra pertenencia a la Unión Europea, pero sin irnos tan lejos en el último año ha llegado también la primera
norma de reutilización del agua. Ello ha llevado a las empresas a incrementar sus propias exigencias de producción para poder ser más eficientes
En lo referido a innovación destacaría la aportación de Hanna instruments en las medidas en campo o in situ de la gran mayoría de parámetros electroquímicos, fotométricos y de turbidez, siendo pionero en su momento en los primeros medidores de bolsillo, sacando de la lejanía de los instrumentos de laboratorio. De esta forma se ha ayudado también con los equipos de campo implicando a todos en la toma de decisiones más inmediata, dando así una mejor productividad y eficiencia
3. A nadie se le escapa que el agua es un bien escaso y la tendencia en general cara al futuro va a ser un tema recurrente y estratégico. Ello nos llevará inexorablemente a la reutilización de aguas y entrará de lleno la tan nombrada inteligencia artificial con el fin de regular y optimizar los recursos existentes de forma global entroncando todo ello mediante técnicas analíticas instrumentales para el control y análisis de todos los parámetros recurrentes referidos al agua. El área de I+D+i de Hanna instruments lleva varios años desarrollando instrumentos inteligentes, así como sistemas digitales de gestión con inclusión de algoritmos IA para en un futuro integrar y facilitar los procesos específicos de cada usuario previendo los diferentes escenarios presentes y venideros.

Valeria Agudelo, Managing Director
1. Desde 1969 hasta hoy, el sector del análisis ha vivido una auténtica revolución. Hemos pasado de técnicas manuales

y procesos fragmentados a sistemas automatizados, precisos y conectados. La digitalización, la miniaturización de equipos y la integración de software inteligente han sido pilares clave en esta transformación. En IKA hemos acompañado esta evolución ofreciendo soluciones que no solo optimizan los procesos analíticos, sino que también garantizan trazabilidad, reproducibilidad y precisión. Hoy, gracias a la tecnología, podemos alcanzar niveles de sensibilidad y exactitud impensables hace apenas unas décadas, elevando así la calidad de los resultados y la confianza en la toma de decisiones.
2. Uno de los mayores retos ha sido, sin duda, mantener la innovación sin perder de vista la sostenibilidad. Las regulaciones cada vez más estrictas especialmente en sectores como alimentación, farmacia o medioambiente han empujado a las empresas a ser más precisas, más rápidas y, al mismo tiempo, más responsables. En IKA hemos respondido con una estrategia basada en la eficiencia energética, el diseño modular y el desarrollo de soluciones más limpias y duraderas. Adaptarnos al cambio no es solo una cuestión de supervivencia, sino de compromiso: con la ciencia, con el planeta y con las personas que usan nuestros equipos día a día. Esa es nuestra brújula.
3. Mirando hacia el futuro, vemos un sector cada vez más conectado, automatizado y autosuficiente. La integración de inteligencia artificial y aprendizaje automático será decisiva en la predicción de resultados, optimización de procesos y en la reducción del error humano. Creemos también que la sostenibilidad dejará de ser un valor añadido para convertirse en un estándar ineludible. En IKA ya estamos trabajando en soluciones que reduzcan aún más el consumo de energía, que prolonguen la vida útil de los equipos y que se integren fácilmente en laboratorios inteligentes. Y si bien las tecnologías cambiarán, el corazón del análisis seguirá siendo el mismo: la búsqueda rigurosa y apasionada de respuestas fiables.


Hugo Newby, CEO
1. “Del laboratorio analógico a la inteligencia instrumental: el futuro se calibra en Instru.es”
“En casi cada laboratorio del mundo se está analizando algo que cambiará el mañana. Nuestra misión es garantizar que ese análisis sea preciso, robusto y ayude a crear un mundo más sostenible y eficaz.”
Desde 1980, Instru.es ha acompañado y potenciado la evolución de la ciencia aplicada en sectores críticos: farma, química fina, petroquímica, medioambiente, energía, agroalimentación y tecnología universitaria, entre otros. Desde nuestra fundación hemos vivido cómo el análisis industrial ha pasado de ser un control de calidad de rutina, a convertirse en un eje de decisiones estratégicas. Hoy, ningún fármaco se lanza, ningún suelo se certifica, ningún residuo se trata, ni se publica una investigación sin el respaldo de datos analíticos sólidos. Y detrás de muchos de esos datos está nuestra empresa tanto con las marcas que representamos como con nuestra propia fabricación. Es la combinación de marcas con tecnología contrastada y nuestra propia fabricación basada en la experiencia de más de 40 años lo que nos permite fabricar productos pensando en todos los ángulos, el conocimiento de la aplicación, el mantenimiento sencillo, la robustez y la calidad de la medida para tener datos fiables con los que nuestros clientes pueden interpretar sus procesos. Entre las transformaciones clave del análisis industrial desde 1969 podemos citar: a) De la precisión manual a la trazabilidad digital. Hemos pasado del espectrofotómetro de banco a sistemas conectados, como por ejemplo vía
OPC-UA y MQTT. Equipos que no solo analizan, sino que dialogan con el entorno productivo, integrándose en sistemas SCADA, MES o LIMS.
b) Del analista al ecosistema conectado. Hoy, los instrumentos son nodos inteligentes dentro de fábricas 4.0 o centros de I+D. Ofrecemos los datos para que los clientes los utilicen desde su nube, ayudamos a que se pueda controlar el análisis desde plantas remotas, y ofrecemos documentación que sirve para que los sistemas predictivos, algunos basados en IAm puedan dar su mayor rendimiento.
c) Normativas que exigen más que cumplir: anticipar. Legislaciones como GMP, ISO 17025, UNE-EN 12873 o EPA Methods ya no son un desafío: son nuestro punto de partida. En Instru.es, más del 95% de nuestros equipos se entregan validados y documentados para auditorías industriales exigentes.
2. Retos y cómo los hemos superado a) Escalabilidad sin perder robustez. El sector demanda sistemas que crezcan con sus procesos. Desarrollamos y ofrecemos soluciones analíticas que permiten a una planta piloto evolucionar hasta producción industrial sin cambiar de equipo, solo de configuración.
b) Reducción de residuos y reactivos. Hemos rediseñado consumos: algunos analizadores usan hasta un 45% menos reactivo por volumen de muestra o bien por el tamaño de muestra que necesitan nuestros equipos, como por ejemplo nuestro equipo de proceso Instran®. En medioambiente y farmacéutica, eso no solo es ahorro: es compromiso regulatorio y reputacional.
c) Formación y soporte científico-técnico. Sabemos que la tecnología es tan buena como quien la opera. Por eso, acompañamos a universidades y centros públicos con transferencia de conocimiento, formación continua y asesoramiento en aplicaciones e I+D desde el primer día.
3. ¿Qué viene en los próximos 10-20 años? “Todo apunta a que el laboratorio será menos un lugar físico y más un sistema inteligente y distribuido.”
1. Desde 1969, el sector del análisis ha experimentado grandes avances en tecnología, metodologías y normativa. ¿Cuáles consideran que han sido los principales cambios que han transformado el sector del análisis desde entonces y cómo han influido en la calidad y precisión de los resultados?
2. El sector del análisis afronta continuamente nuevos retos en cuanto a regulación, innovación y sostenibilidad. ¿Cuáles creen que han sido los mayores desafíos para las empresas del sector durante estos años y cómo se han adaptado a las tendencias cambiantes del mercado?
3. ¿Qué previsiones tienen para el sector del análisis y la evolución de las tecnologías, y qué innovaciones creen que marcarán el sector en los próximos 10 o 20 años?
a) Inteligencia instrumental. Equipos capaces de ajustar sus propios parámetros analíticos según la matriz y el histórico de muestras. Ya estamos trabajando con centros tecnológicos en modelos de autoajuste espectral por machine learning. Desde principios de 2024 estamos construyendo nuestra propia IA para poder ayudar a nuestros clientes.
b) Sensores de campo con precisión de laboratorio. En medioambiente y agro, veremos el salto de sensores portátiles con nivel de certificación metrológica, capaces de validar análisis in situ para decisiones críticas. Prueba de esto es también nuestro analizador Instran®, capaz de medir con métodos colorimétricos, de electrodo selectivo o valoración con la precisión del laboratorio gracias a potente sistema de dosificación totalmente controlado por nuestro software
c) Gemelos digitales de procesos analíticos. Simulaciones virtuales de en-
tornos de laboratorio que predicen el rendimiento y estabilidad de análisis sin intervención física. Esto cambiará la validación de métodos y la escalabilidad industrial.
d) Laboratorios conectados como activos estratégicos. El laboratorio dejará de ser un centro de coste y será un generador de valor, donde los datos analíticos se transformarán en inteligencia de negocio, reducción de mermas y optimización energética.
Liderar Instru.es es liderar una empresa llena de talento transgeneracional enfocado al conocimiento analítico y a dar la mejor solución a aquellos que mueven el mundo: nuestros clientes. Ser CEO aquí no es solo dirigir una empresa de instrumentación. Es liderar la infraestructura técnica de la verdad científica.
Nuestros clientes no nos piden equipos. Nos piden confianza, visión y fiabilidad. Nos eligen porque en un entorno cada vez más normado, competitivo y digital, saben que si los datos son buenos es porque el instrumento es mejor.
Y en Instru.es no solo diseñamos instrumentos. Diseñamos futuro.

IZASA SCIENTIFIC BY PALEX
Merche Gómez, directora
1. La principal evolución que hemos encontrado ha sido la capacidad para desarrollar sistemas electrónicos que puedan medir y cuantificar de forma absoluta propiedades físicas y/o químicas de la materia. Shimadzu desarrolló el primer detector de espectrometría de masas acoplado a un cromatógrafo de gases en 1971, la idea estaba. Lo que no existía era la posibilidad de disponer de sistemas electrónicos que pudiesen medir de forma tan rápida,
tan precisa y exacta los fragmentos moleculares de los compuestos que se quería medir; esto ha hecho que podamos medir alrededor de 1.000 fragmentos moleculares de forma simultánea. Sin duda, en los últimos años, el desarrollo de la inteligencia analítica ha aportado un salto cualitativo decisivo en cómo se gestionan e interpretan los resultados emitidos por los equipos de medida. Todos estos desarrollos nos permiten medir prácticamente cualquier compuesto, en cualquier matriz a niveles de femtogramos con unos estándares de calidad, precisión y exactitud que hasta ahora no se han alcanzado.
2. El mayor desafío que nos hemos encontrado ha sido ser capaces de desarrollar soluciones analíticas que cumplan con los requerimientos normativos que se han desarrollado en los últimos años. La cantidad de compuestos a analizar es cada vez mayor, los límites legislados son cada vez más bajos y se exigen que los métodos analíticos sean más exactos y precisos, además hay sectores de la Industria que exigen software que garanticen la integridad de los datos que se generan. Todos estos condicionantes suponen que los fabricantes de instrumentación analítica deben desarrollar sistemas más capaces y software de gestión más completos, no solo para cubrir las necesidades actuales, sino para prepararse para un futuro cercano cada vez más legislado en condiciones más exigentes. Un ejemplo lo podemos encontrar en el sector medioambiental, con el Real Decreto 3/2023 sobre la calidad de agua de consumo; se incluyen muchos compuestos emergentes con límites de cuantificación muy bajos que es necesario analizar para garantizar la calidad del agua que consumimos.
3. Creemos que los siguientes pasos que se den en este sector estarán encaminados a la automatización de procesos, tanto en el procesado y preparación de muestras como en la evaluación de los resultados obtenidos. En este sentido la inteligencia artificial está desarrollando soluciones realmente innovadoras que permiten avanzar hacia una eva-

luación de resultados más robusta que permita orientar las soluciones que se den en función de los resultados de una forma más efectiva y robusta.

J.P. SELECTA
Jordi Puig Herrera, director
1. Desde 1969, el sector del análisis ha experimentado avances significativos en tecnología, metodologías y normativas, impulsados por una estrecha interrelación entre los avances científicos y la evolución tecnológica, siendo ambos aspectos inseparables.
En J.P. Selecta hemos sido protagonistas activos de esta evolución, especialmente en la instrumentación tecnológica. Uno de nuestros equipos más destacados son las autoclaves, cuya mejora continua ha estado impulsada por la demanda del mercado y la constante actualización de la normativa europea. Año tras año, hemos incrementado la precisión y fiabilidad de estos equipos hasta niveles cercanos a la perfección. Este avance ha contribuido notablemente a evitar contaminaciones cruzadas en experimentos científicos, previniendo falsos positivos y resultados erróneos, además de mejorar sustancialmente la seguridad biológica en los laboratorios, protegiendo así la integridad del operario. Asimismo, nuestros incubadores han experimentado notables mejoras, especialmente en la precisión del control de temperatura, lo que ha incrementado exponencialmente el rendimiento en cultivos microbiológicos y celulares. De manera general, la implementación de sistemas de control PLC y la incorporación de sondas avanzadas han aumentado la exactitud y reproducibilidad en todos nuestros equipos de análisis, pro-

porcionando resultados mucho más precisos y fiables.
En definitiva, los avances tecnológicos en la instrumentación analítica, impulsados por desarrollos científicos y normativas cada vez más exigentes, han sido fundamentales para transformar el sector, mejorando significativamente la calidad, seguridad y precisión en los resultados obtenidos en laboratorios e investigaciones científicas.
2. El sector del análisis ha afrontado continuamente nuevos retos relacionados con la regulación, la innovación tecnológica y la sostenibilidad. En los últimos años, uno de los mayores desafíos para las empresas ha sido adaptarse al incremento significativo en las exigencias tanto de las agencias reguladoras como de los laboratorios clientes, lo que ha impulsado a las compañías a fortalecer sus sistemas internos de calidad y control. En el caso concreto de J.P. Selecta, la empresa ha realizado importantes adaptaciones en respuesta a estas exigencias crecientes. Uno de los pasos fundamentales ha sido la implementación, desde hace varios años, de un departamento específico de calidad encargado de verificar que cada equipo producido cumpla rigurosamente con la normativa vigente. Además, se llevan a cabo pruebas exhaustivas utilizando numerosas sondas y sensores para asegurar la precisión máxima y minimizar cualquier posible error. En materia de sostenibilidad, J.P. Selecta ha apostado por aumentar considerablemente su compromiso ambiental mediante la instalación de placas solares en la fábrica. Esta iniciativa permite incrementar sustancialmente el uso de energías renovables, reduciendo así la huella ecológica de sus procesos productivos. Paralelamente, la empresa también realiza análisis exhaustivos de sus proveedores de materias primas para asegurar que estos cumplan con altos estándares de sostenibilidad.
Otro aspecto clave ha sido la formación proporcionada al consumidor final. Reconociendo que el usuario es quien finalmente utilizará el equipo, J.P. Selecta ofrece capacitación especializada, brindando recomendaciones claras y específicas sobre
cómo manejar correctamente los equipos.
3. En los próximos años, el sector del análisis tecnológico y científico estará marcado por una transformación profunda gracias a la integración de la inteligencia artificial (IA) en los equipos de laboratorio. Esta fusión permitirá no solo optimizar los procesos de análisis, sino también avanzar hacia sistemas capaces de realizar predicciones, interpretaciones y funciones complejas de manera inmediata, precisa y automatizada. Una de las innovaciones clave será el desarrollo de equipos inteligentes capaces de aprender continuamente de cada experimento realizado por el usuario. Esto abrirá la puerta a laboratorios altamente autónomos, donde la IA, alimentada por bases de datos dinámicas y en constante expansión, permitirá una evolución constante del conocimiento experimental. Gracias a esta capacidad de aprendizaje, los sistemas no solo ejecutarán tareas, sino que también propondrán mejoras, identificarán patrones no evidentes y ofrecerán soluciones adaptativas en tiempo real. Además, se espera que tecnologías como la computación cuántica, la nanotecnología y la integración con sistemas de blockchain para trazabilidad y seguridad de datos refuercen esta transformación, marcando un antes y un después en la manera de concebir el análisis científico y tecnológico.

1. Desde 1969, el sector del análisis ha experimentado grandes avances en tecnología, metodologías y normativa. ¿Cuáles consideran que han sido los principales cambios que han transformado el sector del análisis desde entonces y cómo han influido en la calidad y precisión de los resultados?
2. El sector del análisis afronta continuamente nuevos retos en cuanto a regulación, innovación y sostenibilidad. ¿Cuáles creen que han sido los mayores desafíos para las empresas del sector durante estos años y cómo se han adaptado a las tendencias cambiantes del mercado?
3. ¿Qué previsiones tienen para el sector del análisis y la evolución de las tecnologías, y qué innovaciones creen que marcarán el sector en los próximos 10 o 20 años?
alta tecnología y precisión que garantizan unas condiciones de temperatura exactas, estables y documentadas, lo que resulta esencial para la calidad, estabilidad y reproducibilidad de los resultados analíticos. Los requisitos de precisión actuales no serían alcanzables sin estos diseños, sobre todo en el análisis farmacéutico, biotecnológico y ambiental.
1. El acondicionamiento térmico en el laboratorio es hoy un ámbito altamente regulado y técnicamente sofisticado. Los sistemas modernos de control de la temperatura son unidades digitales de
2. En los últimos años, los fabricantes de tecnología de control de la temperatura han tenido que ser muy flexibles e innovadores para cumplir los requisitos de un mercado de laboratorios moderno, sostenible y digital. La responsabilidad ecológica, social y societaria ha sido y sigue siendo un reto importante. Si se quiere sobrevivir en el mercado actual, no solo hay que suministrar tecnología de control de temperatura precisa y fiable, sino también soluciones más eficientes desde el punto de vista energético y respetuosas con el medioambiente. Esto requiere el diseño de unidades
de control de temperatura con modos eco, tecnología de control inteligente y refrigerantes naturales, sin comprometer el rendimiento y la precisión.
3. La sostenibilidad con eficiencia energética, conservación de recursos y reducción de CO2 se está convirtiendo en un factor competitivo aún más central. Sin embargo, el desarrollo de la digitalización, la automatización y la conexión en red, así como la inserción de la IA, también desempeñarán un papel importante. Los fabricantes, laboratorios y especialistas que se adapten en una fase temprana tendrán una clara ventaja.

1. Over the past decades, the analytics industry has been fundamentally reshaped by digitalization, automation, and increasingly stringent regulatory frameworks. Key developments include the transition from analogue to digital measurement systems, the emergence of data analytics and AI, and the widespread adoption of international standards such as ISO and GLP. These changes have enhanced precision, reproducibility, and traceability, resulting in more accurate and reliable outcomes across laboratory and industrial applications.
2. Throughout the years, companies have faced major challenges—chief among them the need to keep pace with evolving regulations, integrate emerging technologies, and respond to increasing sustainability expectations. In meeting these demands, many have invested heavily in research and development, embraced digital and
automated processes, and aligned their products with international standards. Sustainability has become a strategic priority, prompting the development of energy-efficient devices, long-lasting components, and environmentally responsible manufacturing practices. In this dynamic landscape, adaptability and innovation remain essential to longterm success.
3. Looking ahead, the analytics industry is likely to be driven by AI-powered data interpretation, advanced sensor technologies, and seamless integration into IoT-based systems. Equipment will become increasingly autonomous and predictive, operating as part of connected digital ecosystems. Developments such as miniaturization, real-time cloud monitoring, and sustainable product design will also gain prominence. The overall trend will move away from isolated measurements toward intelligent, networked solutions that support faster, data-driven decision-making.

Dr. Gunther Wobser, President & CEO
1. Summarizing the transformative changes in laboratory analytics over the past 56 years is challenging due to the tremendous technological evolution across multiple dimensions of our industry. The integration of microprocessors revolutionized laboratory equipment, with Lauda introducing the world’s first microprocessor-controlled thermostat (KP 20) at ACHEMA 1982. The transition from a seller’s to a buyer’s market –starting already in the 1970s– fundamentally changed our approach to product development,

leading to modular design systems that became industry standards. Digital transformation has dramatically enhanced precision and automation capabilities while simultaneously increasing reproducibility and reducing human error. Environmental considerations have reshaped the industry, with Lauda responding through ecofriendly refrigerants and sustainable technologies.
2. The accelerating pace of technological advancement has required continuous adaptation, demanding substantial investment in R&D to maintain market leadership. Global competition and market consolidation have pushed manufacturers to expand strategically, with Lauda responding through significant global expansion that now includes 14 production and distribution companies worldwide including our band new production plant in Terrassa, Spain. Increasingly stringent regulatory frameworks have necessitated rigorous compliance processes while simultaneously driving innovation in product design. The skilled labor shortage presents an ongoing industry challenge, requiring companies to invest in automation while developing robust training programs. Sustainability has emerged as both a challenge and opportunity, which is reflected in our silver medal in the globally recognized EcoVadis certification.
3. Artificial intelligence integration will fundamentally transform laboratory equipment, enabling predictive maintenance, autonomous optimization, and unprecedented levels of process control in temperature control equipment and systems. Digitalization will create fully connected lab ecosystems allowing seamless data exchange between instruments while creating new opportunities for efficiency and insight. Sustainability will move from competitive advantage to basic requirement, with Lauda already positioning itself through environmentally friendly refrigerants and energy-efficient designs. Supply chain resilience and manufacturing agility will become critical competitive

factors as global dynamics continue to evolve. Service models will increasingly shift to outcome-based solutions, with our recently introduced “5-Year BestWarranty” program already representing steps in this industry-wide transformation.

1. En estas décadas hemos sido testigos de una transformación profunda que va mucho más allá de la instrumentación. La trazabilidad, la automatización y la estandarización de procesos han cobrado un papel clave en la búsqueda de resultados más precisos y reproducibles. Uno de los grandes avances ha sido reconocer la importancia de todos los pasos previos al análisis: la preparación del material, la limpieza y descontaminación del vidrio de laboratorio o la validación de condiciones de trabajo. Hoy en día, garantizar un entorno libre de impurezas y con procesos reproducibles es tan crucial como la tecnología analítica en sí. La fiabilidad del resultado empieza, muchas veces, en aquello que no se ve a simple vista.
2. Adaptarse a marcos regulatorios más exigentes y a un entorno que demanda innovación sostenible ha obligado a mirar cada fase del proceso analítico con nuevos ojos. La limpieza y descontaminación del material de laboratorio, por ejemplo, ya no se entienden únicamente como un paso previo, sino como un eslabón estratégico para asegurar la validez de los ensayos. Las empresas han tenido que integrar soluciones más eficientes, que garanticen no solo la seguridad del proceso, sino también la optimización del consumo de recursos como agua, energía y detergen-
tes. La apuesta por tecnologías más sostenibles y procesos más inteligentes ha sido clave para responder con responsabilidad a los desafíos del presente.
3. En los próximos años, veremos cómo se consolidan entornos de laboratorio más automatizados, interconectados y sostenibles. La trazabilidad completa de los procesos -desde la preparación del material hasta el análisis final- será un estándar. La digitalización, el control remoto y los sistemas de validación integrados permitirán no solo mejorar la eficiencia, sino también reforzar la seguridad de los datos y la calidad de los resultados. La innovación vendrá también de esas soluciones que, sin estar en el foco del análisis, garantizan que cada paso anterior se realice bajo las condiciones más exigentes de higiene, control y reproducibilidad. Porque en un laboratorio del futuro, cada detalle cuenta.

Manuel Muguiro, Channel Sales Manager Spain & Portugal / Digital & Channel Business
1. En efecto, el sector del análisis ha experimentado cambios significativos que han transformado la calidad y la precisión de los resultados. Estos cambios han sido posibles gracias fundamentalmente a los avances tecnológicos. Sartorius es una prueba de ello; durante sus 155 años de historia ha sido y es parte de la solución, en todas y cada una de sus áreas de negocio, permitiendo nuevos instrumentos para análisis más precisos y para las aplicaciones más complejas asegurando al mismo tiempo la calidad, la fiabilidad y la consistencia de los resultados.
1. Since 1969, the analytics industry has seen major advances in technology, methodologies, and regulations. What do you think have been the main changes that have transformed the analytics industry since then, and how have they influenced the quality and accuracy of results?
2. The analytics industry continually faces new challenges in terms of regulation, innovation, and sustainability. What do you think have been the biggest challenges for companies in the sector over the years, and how have they adapted to changing market trends?
3. What are your predictions for the analytics industry and the evolution of technologies, and what innovations do you think will shape the industry in the next 10 to 20 years?
2. Para adaptarse a estos desafíos en los últimos años, las empresas han adoptado estrategias como la digitalización, la inversión en talento especializado, la colaboración con instituciones académicas y de investigación para mantenerse a la vanguardia de la innovación. Durante toda su historia Sartorius lleva invirtiendo en sistemas de cumplimiento para asegurarnos de que nuestros procesos y productos cumplen con las normativas internacionales. Hoy en día uno de los grandes desafíos es la sostenibilidad. En Sartorius, la sostenibilidad está en el núcleo de lo que hacemos. Nuestras tecnologías aceleran el progreso en la investigación y la producción biofarmacéutica, permitiendo un mejor acceso a la atención médica para pacientes de todo el mundo. Nuestra empresa está comprometida a corto plazo (2030) en reducir las emisiones de CO2 y en conseguir el 100% de la energía eléctrica a través de fuentes renovables, minimizar
el uso del agua, reducir las aguas residuales y -obviamente- la contaminación.
3. Hablar de previsiones para el sector del análisis a 10 o 20 años vista es bastante difícil, sobre todo cuando la inestabilidad económica y geopolítica está presente cada día en nuestras vidas. Sin duda, una evolución significativa que impulsará las innovaciones tecnológicas será el uso de la inteligencia artificial. Creo que todos esperamos que el aprendizaje automático juegue un papel crucial en la mejora de los procesos analíticos actuales. En Sartorius los avances continuarán transformando el análisis en el sector de la salud, permitiendo diagnósticos más rápidos, personalizados y tratamientos adaptados a las necesidades individuales de los pacientes. Estas innovaciones no solo mejorarán la precisión y la eficiencia de los análisis, sino que también abrirán nuevas oportunidades a otras industrias. Todas aquellas empresas que adopten estas nuevas tecnologías y que reduzcan el impacto ambiental estarán mejor posicionadas para liderar el mercado y responder a las demandas cambiantes de los consumidores.

Anna María Pastor, directora de Marketing
1. Si pudiéramos viajar en el tiempo y ver un laboratorio en 1969, el año en que vio la luz TdL, la revista referente en nuestro sector, encontraríamos a lo sumo uno de los primeros cromatógrafos de gases españoles, pocos o ningún procedimiento estandarizado de trabajo y una escasa o incipiente normativa. La irrupción de la HPLC en la década de los 70, junto con otras técnicas instrumentales, ha transformado significativa-
LABMAS (Asociación Española de Proveedores del Laboratorio) también nos saluda
Una colaboración fructífera
Desde sus inicios, LABMAS ha mantenido una estrecha colaboración con Técnicas de Laboratorio
A través de reportajes, entrevistas y análisis especializados, la revista ha desempeñado un papel clave en la visibilidad y el crecimiento del sector.
Reconocimiento
a una trayectoria de excelencia “El compromiso de Técnicas de Laboratorio con la información rigurosa y su apoyo al sector han sido invaluables. Su número 500 es un hito que refleja la dedicación y profesionalidad de su equipo. Desde LABMAS queremos felicitarles por este logro y reafirmar nuestro compromiso de seguir colaborando en el futuro”,


destaca Álex Canals, presidente de LABMAS.
Mirando hacia el futuro
Con motivo de esta efeméride, LABMAS reafirma su voluntad de continuar trabajando juntos para impulsar la innovación, la sostenibilidad y la excelencia en el sector de los suministros de laboratorio. Estamos seguros de que esta colaboración seguirá brindando grandes beneficios a la comunidad científica y empresarial.
mente los laboratorios. Estas técnicas han mejorado la precisión y reproducibilidad de los análisis, así como la capacidad de detección y cuantificación de sustancias en muestras complejas, contribuyendo al desarrollo de la ciencia y la industria. La implementación de normativas y estándares internacionales ha mejorado la calidad y consistencia de los resultados de laboratorio. Normas como la ISO 9001 y la ISO 17025 han asegurado la fiabilidad y validez de los análisis, estableciendo un marco de calidad que ha sido adoptado globalmente.
El sector del análisis no ha sido ajeno a los cambios generales de la sociedad en este medio siglo, como la digitalización y la creciente participación de la mujer en el entorno profesional. La digitalización ha permitido una mejor gestión de datos y trazabilidad, mientras que la inclusión de más mujeres en el campo ha enriquecido el entorno laboral con diversas perspectivas y habilidades.
2. Los mayores desafíos para las empresas del sector del análisis han sido la adaptación a regulaciones cambiantes incluyendo el aumento en los límites de los contaminantes, la innovación tecnológica y la sostenibilidad. En este contexto, Scharlab ha demostrado un compromiso continuo con la calidad y el medioambiente. Desde 1995, la empresa ha implementado un sistema de
calidad conforme a la norma ISO 9001, y desde 2002, un sistema de gestión ambiental según la norma ISO 14001. Además, Scharlab cumple con los requisitos de la ley española 31/1995 sobre prevención de riesgos laborales. El logro más reciente es la certificación bajo la norma ISO 13485 en 2024 para productos sanitarios y dispositivos médicos. Estos esfuerzos aseguran que Scharlab cumpla con las normativas internacionales y mantenga altos estándares de calidad y consistencia en sus productos. Ubicada en una zona rural rodeada de bosque, la preservación del medioambiente es una de las principales preocupaciones de Scharlab. La empresa trabaja para garantizar que los recursos naturales y las materias primas se empleen de manera eficiente. Sus instalaciones han sido diseñadas para minimizar el impacto ambiental. Scharlab también ha invertido en la mejora continua de sus productos y procesos. Los departamentos de la empresa se enfocan constantemente en mejorar sus equipos, productos y servicios, asegurando un alto estándar de calidad. Además, la empresa ha adoptado nuevas tecnologías y técnicas analíticas avanzadas para mejorar la precisión y reproducibilidad de los análisis.
3. Si pudiéramos usar de nuevo la máquina del tiempo, pero en este caso para viajar

hacia el futuro, posiblemente veríamos un laboratorio con tecnologías más evolucionadas para dar respuesta a la necesidad de mayor precisión, eficiencia y sostenibilidad. Las técnicas analíticas no pararán de avanzar. Se espera que técnicas avanzadas como la espectrometría de masas y la resonancia magnética nuclear se vuelvan más accesibles y eficientes, mejorando la capacidad de detección y cuantificación de compuestos. Por otro lado, es posible que el propio usuario lleve a cabo más análisis que ahora utilizando test rápidos. En el laboratorio del futuro, la inteligencia artificial (IA) y el aprendizaje automático tendrán un papel destacado en los procesos analíticos, permitiendo análisis predictivos más precisos y la automatización de tareas complejas. La digitalización de los laboratorios y la conectividad de los equipos permitirán una mejor gestión de datos y una mayor colaboración entre equipos de investigación a nivel global. Las empresas del sector seguirán invirtiendo en tecnologías que reduzcan el impacto ambiental y mejoren la eficiencia energética de las operaciones. Las personas estarán más concienciadas y exigirán más información a los productores. La responsabilidad social corporativa seguirá conquistando más terreno en una sociedad donde el talento es cada vez más difícil de retener.

Friedhelm Rickert, fundador y director
1. Desde los años sesenta, el sector se ha ido desarrollando desde métodos principalmente de química húmeda, como la valoración, hasta el análisis instrumental. Se añadieron métodos espectrométricos y cromatográficos, así como la espectrometría de masas. Esto
ha tenido repercusiones en la precisión, la reproducibilidad y el rendimiento de las muestras (eficiencia económica).
2. Se han incorporado y comercializado las innovaciones de la investigación y de la ciencia mediante el diseño industrial de unos dispositivos adecuados. El reto consistía, por un lado, en sacar al mercado dispositivos flexibles que estuvieran a la altura de los últimos avances de la investigación y, por otro, en garantizar la eficiencia económica de los laboratorios bajo contrato. Los dispositivos comerciales se fueron automatizando en gran medida mediante controles adecuados para permitir su manejo por personal de laboratorio con una formación básica. Esta tendencia se ha visto reforzada por una mayor conciencia de la calidad y del medioambiente.
3. Se sigue trabajando en la velocidad de medición y la sensibilidad de detección. Además, se seguirá trabajando en la conexión en red de los distintos sistemas.

1. Desde 1969, el sector del análisis ha experimentado grandes avances en tecnología, metodologías y normativa. ¿Cuáles consideran que han sido los principales cambios que han transformado el sector del análisis desde entonces y cómo han influido en la calidad y precisión de los resultados?
2. El sector del análisis afronta continuamente nuevos retos en cuanto a regulación, innovación y sostenibilidad. ¿Cuáles creen que han sido los mayores desafíos para las empresas del sector durante estos años y cómo se han adaptado a las tendencias cambiantes del mercado?
3. ¿Qué previsiones tienen para el sector del análisis y la evolución de las tecnologías, y qué innovaciones creen que marcarán el sector en los próximos 10 o 20 años?
todo este cambio va acompañado de unas inversiones elevadas para adquirir los equipos capaces de garantizar un correcto cumplimiento de la normativa.
1. La normativa y la precisión han sido las grandes impulsoras de los avances en el ámbito de la analítica. Los cada vez más estrictos controles y regulaciones han exigido que la precisión siempre estuviera a la altura para poder garantizar una seguridad óptima en todos los productos que están bajo el control exhaustivo de las autoridades, ya sean alimentarios, ambientales o farmacéuticos.
2. Uno de los grandes retos del sector ha sido la constante necesidad de formación de los técnicos y supervisores de los laboratorios para no quedarse atrás en cuanto a la normativa, sin olvidar que
3. Parece imposible no nombrar a la inteligencia artificial cuando miramos hacia adelante; parece claro que de una manera u otra la adopción de esta tecnología podrá ayudarnos a centrar los esfuerzos en seguir velando por la seguridad de todo lo que consumimos y -en consecuencia- analizamos. El tiempo adicional que nos debería aportar esta tecnología tendríamos que ser capaces de poder invertirlo en detectar más y mejor. No olvidemos que el sector del análisis es probablemente nuestra mejor herramienta para poder garantizar que lo que consumimos es solamente aquello que queremos consumir, sin impurezas ni moléculas que puedan no ser respetuosas con nuestros organismos.

En nuestro editorial nos referimos de manera palmaria al hecho que motiva esta breve parada en el camino: la llegada del número 500 de Técnicas de Laboratorio. Traducido este dato a tiempo, nos asomamos a algo más de 56 años de historia y en este artículo ofrecemos unas pinceladas relativas al país, a su industria, a la revista y a cómo era esta al principio y cómo ha evolucionado.
Algo sobre el país
En los años 70, España atravesaba una etapa de transición política y económica significativa. Durante la dictadura franquista, el país mantenía una estructura autoritaria, pero en aquellos años que vieron los primeros números de Técnicas de Laboratorio comenzaba a experimentar cambios importantes que culminarían en la transición a la democracia a finales de la década, tras la muerte de Franco en 1975. En el ámbito económico, España se encontraba en un proceso de industrialización acelerada, impulsada por políticas de desarrollo económico que buscaban modernizar el país, con décadas de profundo retraso tras un período regido por la autarquía. A pesar de estos avances, la sociedad española seguía siendo mayoritariamente rural y conservadora, con una gran disparidad entre las zonas urbanas e industriales -como Madrid y Barcelona- y las áreas rurales.
La crisis del petróleo de 1973 tuvo un impacto considerable en la economía española, como en muchos otros países. España dependía en gran medida de las importaciones de petróleo, y el aumento de los precios del crudo disparó la inflación, afectando al poder adquisitivo de la población. Cabe recordar al respecto aquel lema referido a la energía (gas, electricidad…), “Aunque usted pueda pagarla, España no puede”. Además, la crisis contribuyó a una desaceleración
económica que provocó una caída en el crecimiento industrial, que conllevó un aumento del desempleo y de las tensiones sociales. Este contexto de incertidumbre económica y cambios políticos agravó las desigualdades entre los segmentos de la población e hizo crecer el malestar en sectores como los obreros y las clases medias, que demandaban reformas. La década de 1970 fue en España un periodo de transformación profunda, marcado por la lucha por la democracia y los efectos de la crisis económica global.
En los últimos 56 años (si nos atenemos a la fecha de nacimiento de Técnicas de Laboratorio), la industria española ha experimentado una profunda transformación que ha marcado su estructura y competitividad en el ámbito mundial. En los setenta, España tenía una economía predominantemente agrícola con una industria poco desarrollada. El proceso de modernización que comenzó con la transición democrática en 1975 se consolidó en los años 80, cuando España se integró en la Comunidad Económica Europea (hoy Unión Europea). Esta adhesión propició una mayor apertura al mercado global, una importante inversión en infraestructuras y el impulso a sectores clave como la química, la automoción, y la maquinaria, en los que actualmente ostenta un papel de gran importancia en el contexto internacional.

Ya en la década de 1990, la reestructuración industrial fue un desafío, ya que España vivió una desindustrialización parcial debido a la deslocalización de algunas fábricas a países con menores costes laborales (algo que sucedió también en numerosos países del entorno). No obstante, la digitalización y la innovación tecnológica, con el auge de la electrónica y las telecomunicaciones, lograron revitalizar ciertas industrias.
El siglo XXI ha estado marcado, por ahora, por la consolidación de la industria del automóvil, el crecimiento de las energías renovables y también de la biotecnología, además de por un sector turístico que impulsa significativamente (y de manera tal vez excesiva, todo hay que decirlo) la economía. En la actualidad, la industria española se enfrenta a los mismos retos que el resto del mundo, como la sostenibilidad, la automatización y la transición energética. Sin embargo, la diversificación de sectores, la incorporación de la digitalización y la industria 4.0 siguen siendo claves para garantizar su competitividad futura.
Técnicas, instrumentos y métodos analíticos
Desde 1969 hasta hoy, la evolución técnica de la instrumentación y los métodos analíticos en los laboratorios ha experimentado avances significativos que han transformado la manera en que se realizan los análisis científicos. Estos avances han permitido obtener resultados más rápidos, precisos y detallados, abriendo nuevas posibilidades en campos como la química, la biología, la farmacología y la ingeniería ambiental, por citar solo algunos. A continuación, y a modo de ejemplo (sería prolijo repasar todos los campos en los que incide la revista) se describen algunos de los desarrollos más importantes en este periodo, en lo tocante a la cromatografía, la espectrometría y la medición de parámetros físicos.
· Cromatografía
La cromatografía ha sido uno de los campos más dinámicos en términos de evolución técnica. En 1969, la cromatografía en columna y la cromatografía de capa fina (CCF) eran los métodos más utilizados, aunque con limitaciones en cuanto a tiempo de análisis y resolución. La introducción de la cromatografía líquida de alta resolución (HPLC) en los setenta permitió una separación más eficiente y precisa de componentes en muestras complejas, lo que supuso un avance fundamental en la calidad de los análisis. Con el tiempo, la HPLC se combinó con sistemas de detección más avanzados, como los detectores UV, de fluorescencia y de masas. A finales de la década de 1990 y principios de 2000, la cromatografía de gases acoplada a espectrometría de masas (GC-MS) comenzó a ser común, permitiendo la identificación de compuestos con mayor precisión y en menores concentraciones.


En el ámbito de la espectrometría, los avances más notables se han dado en la espectrometría de masas (EM) y la espectrometría atómica. En 1969, los espectrómetros de masas eran voluminosos y tenían una resolución limitada. Sin embargo, a medida que avanzaba la tecnología, se desarrollaron espectrómetros más pequeños, rápidos y con mayor resolución, como los espectrómetros de masas de alta resolución y los espectrómetros de iones de arrastre. Los avances en la espectrometría de masas se vieron complementados por la aparición de la espectrometría de absorción atómica (AA) y la espectrometría de emisión atómica (AES), tecnologías que permitieron la medición precisa de elementos traza en diversas matrices.
A partir de la década de 1990, la espectrometría de masas se combinó con la cromatografía, dando lugar a técnicas de análisis potentes como la cromatografía líquida acoplada a espectrometría de masas (LC-MS), que ofrecieron nuevas posibilidades en la cuantificación y la identificación de compuestos orgánicos.
En cuanto a las mediciones de parámetros físicos, la evolución ha sido igualmente impresionante. Desde 1969, las técnicas para medir parámetros como temperatura, presión, pH, conductividad, viscosidad y otros, han mejorado en precisión y capacidad


de automatización. Los sensores electrónicos han revolucionado este campo, y hoy en día se utilizan sensores avanzados capaces de medir con alta precisión y en tiempo real.
La incorporación de tecnologías como la espectroscopía infrarroja, la resonancia magnética nuclear (RMN) y la fluorescencia también ha permitido obtener información detallada sobre estructuras moleculares, interacciones químicas y propiedades físicas de las sustancias en estudio.
En resumen, la evolución de la instrumentación y los métodos analíticos desde 1969 hasta la actualidad ha sido impulsada por el desarrollo de tecnologías más precisas, rápidas y automatizadas. El impacto de estos avances ha sido fundamental no solo para mejorar la calidad y la fiabilidad de los resultados obtenidos en los laboratorios, sino también para abrir nuevas fronteras en áreas como la farmacología, la biotecnología, la ecología y la ciencia de materiales, entre otras.
La revista en sí,
Desde 1969, las revistas técnicas en España y, por supuesto, Técnicas de Laboratorio, han experimentado una notable evolución tanto en su maquetación como en sus procesos de impresión y distribución. En sus primeros años, las revistas seguían un formato tradicional con maquetaciones estáticas, predominando los diseños simples y textos extensos, a menudo en blanco y negro debido a las limitaciones tecnológicas y económicas de la época. Lo habitual era redactar los textos y enviarlos a empresas que los “picaban” en los tipos y cuerpos de letra y anchos de columna solicitados, para después montar las páginas una a una a base de tijeras, reglas y encajes y después encargar los fotolitos para la impresión, que era predomi-


nantemente offset, un proceso que, aunque de cierta calidad, resultaba costoso.
Actualmente es difícil creer que las revistas se produjeran de aquel modo y, sin embargo, llegaran a las ferias, por ejemplo, cuando estaba previsto. Las anécdotas suscitadas por aquel sistema productivo darían para páginas y páginas…
A medida que avanzaba la tecnología, la introducción generalizada de la informática en la década de 1980 permitió la adopción de programas de diseño que facilitaron una maquetación más dinámica y visualmente atractiva. La transición al color en las revistas fue otro hito importante, especialmente ya en los 90, cuando las técnicas de impresión digital y la mejora en la calidad de las tintas y los papeles hicieron posibles tiradas más económicas y de mayor calidad.
En cuanto a la distribución, las revistas técnicas pasaron de depender exclusivamente de canales físicos (quioscos y, en el caso de esta revista, suscripciones y algunas librerías técnicas) a integrar plataformas digitales a partir del cambio de siglo. El acceso a internet y la digitalización transformaron la distribución, permitiendo la publicación en línea y la interacción directa con el público objetivo, adaptándose al nuevo entorno multimedia y ampliando enormemente las posibilidades comunicativas.
Técnicas de Laboratorio nació como revista bimestral y a lo largo de los años ha ido adaptando su periodicidad a las necesidades de los lectores y del sector en general y actualmente se edita diez veces al año, si bien las newsletters se lanzan con una periodicidad notablemente más corta para mantener al lector perfecta y puntualmente informado.
Vamos ahora por 500 números más… ¡por lo menos!
expoquimia
Técnicas de Laboratorio es algo más joven, ya que su primer número vio la luz en abril de 1969, pero desde entonces feria y revista, revista y feria, han seguido caminos paralelos prestando todo el apoyo

Son numerosas las ferias a las que ha asistido Técnicas de Laboratorio, pero sin duda, por proximidad y afinidad geográfica (ambas entidades son 100% barcelonesas), la relación más estrecha siempre ha sido la establecida con Expoquimia, que nació en 1965 en el recinto ferial de Montjuïc de Fira de Barcelona bajo la denominación de Feria Técnica de la Química Aplicada. Un expositor en 1965
posible a los respectivos sectores, que a menudo se intersecaban de manera muy marcada.
La excepcional coyuntura económica que para la industria química española
supusieron los años 60, unida a un creciente mercado interior y a un desarrollo tecnológico capaz de competir en el mercado extranjero, despertaron la necesidad de dar a conocer y promocionar la realidad del sector químico español.


1975
En este clima de optimismo se firmó el 17 de febrero de 1965 un convenio entre la Feria de Muestras de Bilbao, la Cámara Oficial de Comercio de Madrid y la Feria Oficial e Internacional de Muestras de Barcelona, la actual Fira de Barcelona, para la celebración de certámenes de la industria química en las tres capitales.
1965: nace Expoquimia
Del 3 al 14 de diciembre de 1965 tuvo lugar la Primera Feria Técnica de la Química aplicada, Expoquimia’65. Su presidente, José Agell, expuso como objetivo prioritario del evento mostrar el extraordinario desarrollo de la industria química en España, que superaba en un 50% al resto de los sectores industriales.
Aquella primera edición, reunió 226 expositores y 151.421 visitantes. Expoquimia’65 demostró en Barcelona la rentabilidad de este tipo de encuentros. Las transacciones económicas efectuadas, las relaciones y contactos profesionales establecidos, la importante afluencia de visitantes relacionados con la industria
química y paraquímica, confirmaron el éxito del evento.
1968: inicio de la proyección internacional
En su segunda convocatoria, la demanda de los expositores hizo aumentar en más de un 50% el espacio ferial, constituyendo un fiel reflejo de la industria química española, que ocupaba el cuarto lugar en cuanto a su aportación a la renta industrial del país, y el quinto puesto en el concierto europeo, superando incluso a Bélgica y los Países Bajos. En aquella edición, Expoquimia inició su apertura europea, reuniendo más de 300 expositores de 17 países.
1971: nuevas inquietudes de la industria química
La década de los 70 fue crucial para el crecimiento de la industria química española. En la edición de 1971 se puso de manifiesto una rápida evolución tecnológica, con el desplazamiento progre-
sivo de la industria carboquímica hacia la petroquímica. También surgió la necesidad de crear grandes complejos químicos capaces de satisfacer la creciente demanda y competir tanto en precio como en calidad. Uno de los principales atractivos fue una réplica a escala reducida de la plataforma petrolífera Chaparral que se exhibió en la Plaza del Universo del recinto de Montjuïc. La plataforma original, ubicada en las costas de Tarragona, simbolizaba la esperanza de aumentar la extracción de petróleo, siendo un emblema de esa época.
El éxito de Expoquimia en Barcelona, junto con la celebración de otros salones de la química en Europa, impulsó una reflexión sobre las ferias químicas en España. La Unión Nacional de Empresarios del Sector Químico, la Dirección General de Industrias Químicas y de la Construcción, la Feria Oficial e Internacional de Muestras de Barcelona y Expoquimia decidieron solicitar la creación de un único evento nacional, con periodicidad trienal y reconocimiento internacional. Como resultado, en 1973, Expoquimia fue establecida como el evento referen-
te del sector químico en España, con carácter internacional y celebraciones cada tres años.
Expoquimia en el calendario europeo
En la década de los 70, las principales ferias internacionales para la industria química eran ACHEMA en Frankfurt y el Salón de la Chimie en París. Gracias al creciente prestigio de Expoquimia, esta se consolidó como la tercera feria más relevante del sector en Europa. Con su inclusión en el calendario europeo de ferias trienales, Expoquimia debió posponer su cuarta edición, originalmente programada para 1974, celebrándola finalmente en marzo de 1975.
A pesar del contexto complicado debido a la crisis energética de 1973, Expoquimia 1975 demostró que la industria química española estaba dando pasos firmes hacia su consolidación y entrada en la fase de europeización. Bajo la presidencia de Fernando Gimeno Muntadas, aquella edición, reunió a 386 expositores directos y atrajo a 101.500 profesionales.
1978, 1981 y 1984: el reto del Mercado Común
En 1977 se completó el segundo ciclo de inversiones para los programas de desarrollo de la industria química básica. La capacidad de producción instalada permitió un aumento significativo de la producción con una inversión mínima. En este contexto, Europa emergió como el mercado natural para las empresas españolas, que comenzaron a evaluar tanto los retos como las oportunidades estructurales y comerciales que la integración europea traería para el sector. Las ediciones posteriores de Expoquimia en los años 80 reflejaron estas preocupaciones, abordándolas en reuniones empresariales, jornadas técnicas, congresos y contactos personales.
En Expoquimia 1978 se celebraron por primera vez dos acontecimientos internacionales de gran relevancia: el Congreso Mediterráneo de Ingeniería Química, con sesiones sobre ecología, y el Congreso Internacional sobre Técnicas Analíticas en Química Ambiental, que vinculaba ya la química con la protección ambiental.
En 1981, Expoquimia se celebró en medio de una crisis económica. Fue un mal año para la industria química tanto en España como en el resto de Europa, con recesión en subsectores como el plástico. Sin embargo, a pesar de la desaceleración en la participación de ferias a escala continental, la afluencia de visitantes y expositores se mantuvo estable.
Con una internacionalidad del 60%, Expoquimia 1984 reunió a 478 expositores de 25 países y fue la última edición antes de la entrada de España en la Comunidad Europea. Esta edición se celebró, por primera vez, junto a Equiplast (Salón Internacional del Plástico y el Caucho), configurando una plataforma que conectaba los fabricantes de materias primas y los transformadores de estos productos.
Expoquimia’87:
la nueva imagen de la Química española
La edición de 1987 se distinguió por su carácter innovador. La imagen renovada de la industria química y sus empresas

productoras de bienes y servicios se reflejó en la celebración conjunta de Expoquimia, Equiplast y la nueva incorporación de Eurosurfas. Juntos, los tres salones reunieron 891 expositores y más de 150.000 visitantes, configurando el Encuentro de la Química Aplicada del Mediterráneo.
El carácter internacional de estas ferias fue más relevante al ser la primera edición tras la adhesión de España al Mercado Común. Esta ocasión estuvo marcada por el optimismo derivado de este hecho y por la recuperación económica del sector, impulsada por un fuerte aumento de la demanda interna y una mejora de las exportaciones en el ámbito europeo. Además, se celebró la ECMRA Convention’87, evento que reunió a expertos en marketing de empresas químicas de todo el mundo.
Expoquimia’90: posicionamiento global
A pesar de que la Guerra del Golfo generó una gran inquietud en el mundo económico, más de 1.200 expositores directos y un total de 4.000 empresas representadas procedentes de 39 países hicieron de este
vigésimo aniversario un acontecimiento muy especial con una importante proyección no solo europea, sino mundial. La incorporación definitiva de Equiplast y Eurosurfas, formando un bloque homogéneo de oferta, dieron un impulso al posicionamiento internacional de Expoquimia, que llegó a ocupar 70.000 m2
Expoquimia 1993 y 1996: continuidad y consolidación
Las ediciones de 1993 y 1996 fueron menos expansivas que las anteriores, pero estuvieron marcadas por la continuidad y la consolidación. La de 1996 supuso un punto de inflexión en la trayectoria de Expoquimia, Eurosurfas y Equiplast con la celebración de Equiplast en el pabellón ferial inaugurado en 1995 en el polígono Pedrosa de L’Hospitalet de Llobregat, que recibía en aquel entonces el nombre de Montjuïc-2, mientras que Expoquimia y Eurosurfas se mantenían en el emblemático recinto de Montjuïc.
En la edición de Expoquimia 1999, presidida por Rafael Foguet, el número de expositores creció nuevamente, y por primera vez, los conceptos de innovación y competitividad se posicionaron

como los principales retos del sector. Una de las grandes novedades de esa edición fue la creación de un foro de debate económico e industrial, que fue muy bien recibido.
Con la llegada del nuevo milenio, las tendencias en la química comenzaron a centrarse en la bioquímica, impulsada por la biotecnología, y en el desarrollo de nuevos materiales. Expoquimia supo adaptarse rápidamente a estos cambios y, en la edición de 2002, tanto los congresos como las jornadas incluyeron numerosas ponencias relacionadas con estas disciplinas emergentes.
Expoquimia 2005: traslado al recinto de Gran Via
En Expoquimia 2005, los tres salones se celebraron por primera vez en el recinto de Gran Via, con un fuerte enfoque en la I+D+i. La edición contó con la participación de 2.552 empresas de 46 países. Para iniciar el evento, se organizó una jornada monográfica centrada en la biotecnología y la química de nuevos materiales. Fue también en esta edición cuando se otorgaron los primeros Premios Expoquimia a los investigadores jóvenes.
En Expoquimia 2008 se profundizó en esta diversificación con la inclusión de Lab&Bio, espacio que agrupaba a empresas de química fina y principios activos farmacéuticos.
Expoquimia 2011: Año Internacional de la Química
La edición de Expoquimia 2011 fue especialmente relevante al coincidir con el Año Internacional de la Química, proclamado por la ONU para conmemorar el centenario del Premio Nobel de Química otorgado a Marie Curie. A pesar de la crisis económica, el evento reunió a más de 600 expositores de 15 países, quienes presentaron 200 novedades. En línea con las tendencias más recientes, Expoquimia introdujo dos nuevos espacios: Pharma Process, enfocado en la in-
dustria farmacéutica, y Food Innovation, dedicado a las innovaciones químicas en la alimentación. A estos se sumaron Lab&Bio Compositech, orientado a los nuevos materiales, y CosmeticDate, centrado en la cosmética industrial.
Además, Expoquimia fue la sede del 5º Congreso Español y el 16º Iberoamericano de Mantenimiento, así como del Congreso de Ingeniería Química del Mediterráneo. La feria también albergó los actos de clausura del Año Internacional de la Química, consolidando a Barcelona como la capital mundial de la química durante esos días.
Expoquimia 2014: aportaciones de la Química
Más 600 expositores, más de 200 novedades, 160 actividades entre congresos, seminarios, jornadas y presentaciones y casi 38.000 profesionales fueron las grandes cifras de Expoquimia 2014. Fue la primera edición del espacio “Smart Chemistry Smart Future” impulsado por la patronal FEIQUE, en el que se dieron a conocer las aportaciones de la química en ámbitos clave como la energía y el agua, la salud o las Smart Cities. Presidió aquella edición Luis Serrano.
Expoquimia 2017: World Chemical Summit
Con 672 expositores directos, en 2017 Expoquimia, Eurosurfas, Equiplast volvieron a demostrar el papel fundamental que juegan la industria química, la del tratamiento de superficies y la del plástico para el desarrollo socioeconómico actual. Además, a esta oferta comercial se sumó la celebración de la primera edición del World Chemical Summit, foro de debate que dio a conocer las soluciones que plantea la química para resolver los diversos retos que plantea la sociedad actual. El salón acogió, asimismo, el Congreso Mundial de Ingeniería Química. Antón Valero fue el presidente de Expoquimia 2017.

Expoquimia 2021: pandemia y ODS
La edición de Expoquimia 2020 se aplazó hasta 2021 como consecuencia de la pandemia de covid-19. Fue una edición celebrada en un contexto muy complicado pero que consiguió buenos resultados en un ambiente de moderado optimismo. La feria, nuevamente celebrada con Equiplast y Eurosurfas, sirvió para poner en valor el compromiso del sector químico con la economía y la industria, así como su imprescindible papel para alcanzar los Objetivos de Desarrollo Sostenible (ODS) en materia de sostenibilidad medioambiental, social y económica. Participaron 194 expositores y fue la primera edición presidida por Carles Navarro.
Expoquimia2023 circularidad y digitalización
Una edición solo junto a Equiplast que marcó un punto de inflexión para impulsar la cohesión sectorial de la química y el plástico. Sumaron 590 expositores directos, más de 1.500 marcas representadas y 18.882 visitantes. Incluyeron más de 100 actividades de conocimiento y networking con foco en
la economía circular, la digitalización y la transferencia tecnológica como las principales palancas que han de garantizar un futuro sostenible para las industrias. Como gran acto sectorial, se celebró una Cena de Gala de Expoquimia con más de 600 asistentes, entre ellos los principales directivos de las empresas y entidades del sector, que sirvió para visibilizar la potencia de una industria transversal que se reivindica como esencial para catalizar la transformación de los procesos productivos en clave sostenible.
Una renovada
Expoquimia 2026
Después de esta extensa trayectoria, Expoquimia se renueva y prepara su edición de 2026, que tendrá lugar del 2 al 5 de junio junto a Equiplast, con el objetivo de potenciar el papel de la química como motor transformador de las industrias manufactureras. El salón aspira a convertirse de nuevo en referente ferial en el arco mediterráneo mostrando soluciones para que los procesos industriales sean más eficientes y sostenibles. Y Técnicas de Laboratorio estará allí una edición más para contarlo.
Ricardo Díaz Martín atiende a las preguntas de Técnicas de Laboratorio en calidad -en principio- de lo que dice el titular del texto, pero actualmente también es catedrático en Universidad CEU-San Pablo (Ingeniería Química y Materiales) y director Académico de la Fundación CEU - Núñez de Balboa. En todo caso, su CV (aunque no lo parezca, resumido) redondea la presentación de un investigador, docente y profesional con un gran peso específico en el sector. Vamos allá.
¿Cuál ha sido el papel del colegio y cómo ha evolucionado, desde su fundación hasta la actualidad?
El Consejo General de Colegios Oficiales de Químicos de España se constituyó oficialmente en marzo de 1951, integrando a los Colegios Oficiales de Doctores y Licenciados en Ciencias Químicas y Físico-Químicas.
Desde su fundación, el Consejo ha desempeñado un papel fundamental en la representación y defensa de los profesionales de la química en España. A lo largo de las décadas, ha evolucionado adaptándose a los cambios en la profesión y en la sociedad, promoviendo la formación continua, acercando a profesionales e industria con la sociedad, velando por el cumplimiento de la ética profesional y participando activamente
en el desarrollo de políticas relacionadas con la química. En la actualidad, el Consejo integra a profesionales químicos de todos los sectores, contribuyendo al fortalecimiento del estatus y la práctica de la profesión química, defendiendo los intereses de la profesión tanto en España como en otros países.
¿Cómo ha evolucionado la formación y capacitación de los profesionales en el sector químico en España desde los años 70 hasta la actualidad?
Desde los años 70, la formación en el sector químico en España ha experimentado una notable transformación. Inicialmente, la formación de los químicos era muy homogénea y se basaba en una formación muy completa y exigente durante los tres primeros cursos de carrera,
para posteriormente especializarse en alguna rama de las ciencias químicas en los últimos dos cursos de la licenciatura. En el caso de las especialidades industriales, los ingenieros para la industria química se formaban en las Escuelas de Ingeniería Industrial, especialidad Química, y en las Facultades de Ciencias, especialidad de Química Industrial. Hasta 1992 no se crea en España el título de Ingeniero Químico como tal. Hay mucho debate sobre este título porque es cierto que permite una formación más específica y adaptada a las necesidades de la industria química, pero también es verdad que esa fuerte especialización ha limitado áreas importantes y ha dejado algunas lagunas notable comunes a los nuevos grados afines a la química como son bioquímica, biotecnología, ingeniería de materiales, tecnología de alimentos, ciencias ambientales, etc.

Estas lagunas son las referidas a áreas transversales y comunes a dichas titulaciones afines, así como a las denominadas “habilidades blandas”, fundamentales en entornos laborales cambiantes. Es precisamente en estos y otros ámbitos transversales, en los que no se forma específicamente a los químicos, donde el Consejo quiere jugar un papel fundamental, dando un servicio de actualización y formación continua desde su recién creada Escuela Internacional del Consejo.
En términos de avances tecnológicos, ¿cuáles considera que han sido los hitos más importantes en los laboratorios españoles durante las últimas décadas?
En las últimas décadas, los laboratorios españoles han sido testigos de avances tecnológicos significativos que han transformado la práctica científica y analítica. Son muchos los hitos que han marcado su evolución, pero yo destacaría la automatización y robótica, que ha permitido aumentar la precisión y reproducibili-
dad de los análisis, reduciendo errores humanos y mejorando la eficiencia; la espectrometría de masas de alta resolución, que ha supuesto una revolución en la identificación y cuantificación de compuestos químicos, siendo esencial en campos como la proteómica y la metabolómica; las tecnologías de secuenciación de nueva generación, que han facilitado el análisis genómico a gran escala, impactando en el desarrollo de la biotecnología y la farmacología; la microscopia electrónica avanzada, con la que se logra la observación de estructuras a nivel nanométrico, crucial para el desarrollo de nuevos materiales y nanomedicina, y la implementación de sistemas de gestión de información de laboratorio (LIMS), cuyos sistemas han optimizado la gestión de datos y muestras, mejorando la trazabilidad y la eficiencia operativa.
¿Qué impacto ha tenido la digitalización en los métodos y técnicas empleados en los laboratorios?
La digitalización ha tenido un impacto profundo en los laboratorios, transfor-
mando métodos y técnicas tradicionales. De manera general y para todo tipo de laboratorios, en la gestión de datos, la digitalización ha facilitado el almacenamiento, análisis y compartición de grandes volúmenes de datos, mejorando la eficiencia y la colaboración entre equipos; o en el control de calidad, los sistemas digitales permiten un monitoreo en tiempo real de procesos, garantizando la consistencia y calidad de los resultados.
Si observamos algunos ámbitos específicos se puede indicar que, en los laboratorios farmacéuticos, la digitalización ha acelerado el descubrimiento de fármacos mediante simulaciones computacionales y ha optimizado la gestión de ensayos clínicos; en los laboratorios ambientales se han implementado sensores inteligentes y sistemas de monitoreo en tiempo real para la detección y análisis de contaminantes; en los laboratorios de seguridad alimentaria, la trazabilidad de productos ha mejorado con los sistemas digitales que garantizan la seguridad y la gestión eficiente de la cadena de suministro; en los biotecnológicos, la integración de herramientas digitales ha facilitado la manipulación genética y la producción de bioproductos, o en los petroquímicos, la digitalización ha optimizado procesos de refino y producción, reduciendo costes y haciéndolos más eficientes.
No obstante, la generalización de la inteligencia artificial, apoyada en todo el trabajo realizado por la digitalización, va a suponer una autentica revolución en la velocidad de desarrollos y productos y servicios de todo tipo de laboratorios.
¿Qué diferencias clave existen hoy en día entre los métodos tradicionales de laboratorio utilizados en los años 70 y los actuales?
Desde los años 70, los métodos de laboratorio han evolucionado significativamente en aspectos como el equipamiento, donde se ha pasado de equipos manuales y analógicos a
instrumentos automatizados y digitales, aumentando la precisión y reduciendo el tiempo de análisis y, en las técnicas analíticas, algunas actuales, como la cromatografía líquida de alta resolución (HPLC) y la espectrometría de masas, ofrecen mayor sensibilidad y especificidad en comparación con métodos tradicionales. En las metodologías actuales sus enfoques multidisciplinarios y el uso de herramientas bioinformáticas han logrado ampliar significativamente las capacidades de investigación y análisis.
¿Cómo contempla la incorporación de la sostenibilidad y la “química verde” en los métodos de trabajo y en la investigación en el sector?
En la industria química española, la sostenibilidad y la química verde han pasado de ser un concepto teórico a un eje estratégico clave en los métodos de trabajo y en la investigación. En las últimas décadas, la presión regulatoria, la demanda de los consumidores y los compromisos internacionales en materia de sostenibilidad han impulsado cambios significativos en la forma en que las empresas del sector químico operan y desarrollan nuevos productos.
Obviamente, el sector químico es uno de los más sensibles a la sostenibilidad y por ello ha adoptado diversas estrategias como la implementación de los principios de la “química verde”, basados en el uso de materias primas renovables, la reducción de residuos en todos los procesos, la sustitución de reactivos y disolventes tóxicos y la eficiencia energética de cada operación.
Los avances tecnológicos han permitido incorporar soluciones innovadoras que reducen la huella ambiental del sector químico. Los más influyentes han sido la química computacional y el modelado molecular, que han permitido reducir la necesidad de muchos ensayos experimentales; el empleo de energías procedentes de fuentes renovables en las
operaciones industriales y la aplicación de la nano- y la biotecnologías, que han permitido alcanzar nuevos materiales biodegradables.
Es importante reseñar que el marco normativo europeo y español ha sido un motor clave en la transformación sostenible del sector químico. Tener que adaptarse a una regulación tan exigente ha hecho que la industria química se encuentre continuamente fuera de su zona de confort y que se exija una innovación constante. Por una parte, el Reglamento REACH ha obligado a las empresas a reducir el uso de sustancias químicas peligrosas, promoviendo el desarrollo de alternativas más seguras y sostenibles; por otra parte, el Pacto Verde Europeo y la Estrategia de Sostenibilidad de Productos Químicos plantean un horizonte en el que la industria química sea climáticamente neutra y libre de tóxicos en 2050.
Con todo ello, y a pesar de los avances, existen serios desafíos para alcanzar los objetivos marcados. Los altos costes de implementación de las tecnologías más sostenibles hacen inviables a muchas pymes. La solución no es retirar las exigencias regulatorias, sino dotarlas de incentivos económicos y fiscales reales que ayuden a costear la adaptación y la reingeniería de los procesos hacia las tecnologías más limpias. Y no se me puede quedar en el tintero citar que es clave seguir formando a los profesionales del sector en prácticas sostenibles y fomentar la colaboración entre universidades, centros de investigación y empresas.
En el ámbito de la regulación, ¿cómo han cambiado la normativa y las buenas prácticas de laboratorio desde los setenta hasta ahora, y qué desafíos existen en su implementación actual?
Desde los años setenta, la normativa y las buenas prácticas de laboratorio en España han evolucionado significativamente, impulsadas por la armonización
con los estándares internacionales y la necesidad de garantizar la calidad, seguridad y trazabilidad de los procesos analíticos. La implantación de normativas como las Buenas Prácticas de Laboratorio (BPL) de la OCDE y adoptadas en España en 1990 o el Reglamento REACH han establecido requisitos estrictos en la gestión de sustancias químicas y en la validación de métodos analíticos.
Además, normas como la ISO 17025 han reforzado la competencia técnica de los laboratorios de ensayo y calibración, exigiendo un mayor rigor en la documentación y los sistemas de gestión de calidad.
Aunque la digitalización y la automatización han ayudado definitivamente en el cumplimiento de las exigencias normativas, la creciente complejidad de las regulaciones europeas y nacionales supone un desafío para los laboratorios pequeños y medianos, que a menudo se enfrentan a dificultades para cumplir con todos los requisitos sin un aumento en costes y burocracia. La necesidad de formación continua para el personal y la adaptación a nuevas exigencias, como las derivadas del Pacto Verde Europeo, también representan retos importantes.
Sobre los desafíos actuales destacaría la necesidad de armonizar la normativa española con regulaciones globales sin generar barreras innecesarias para la innovación y la competitividad de los laboratorios. Además, la aplicación de criterios más estrictos en materia de seguridad química, sostenibilidad y gestión de residuos exige un esfuerzo adicional por parte del sector para adaptar sus procesos a modelos más ecológicos sin comprometer la eficiencia analítica y el rigor.
Indudablemente, la mejora en la financiación y el acceso a tecnologías avanzadas serán claves para garantizar que los laboratorios españoles sigan cumpliendo con los más altos estándares de calidad y seguridad.
Currículum vitae
Cargos actuales
· Decano – presidente del Consejo General de Colegios Oficiales de Químicos de España.
· Catedrático en Universidad CEU-San Pablo (Ingeniería Química y Materiales)
· Director Académico de la Fundación CEU - Núñez de Balboa
Formación
Licenciado en CC. Químicas por la Universidad Complutense de Madrid con la especialidad de Ciencia de Materiales e Ingeniería Metalúrgica en 1992. Doctor en CC. Químicas por la misma universidad y especialidad en 2001 con una tesis sobre diseño y modelización de biorreactores industriales que obtuvo la calificación de sobresaliente cum laude ante un tribunal formado por profesores de universidades internacionales.
En 2004 obtiene el título de Técnico Superior en Prevención de Riesgos Laborales con sus tres especialidades (Seguridad, Higiene y ergonomía y Psicosociología aplicada).
Experiencia laboral
1999-2004: colabora con diversas empresas tecnológicas dirigiendo trabajos de I+D (Ecowood Logic y Mould Wood) y como técnico garante de la calidad de productos sanitarios.
2012: miembro del Comité Técnico de Normalización 190 de AENOR. 2014-2021: decano del Colegio Oficial de Químicos de Madrid.
En 2015 es nombrado asesor-consultor internacional de la OEA (Organización de Estados Americanos) para el medioambiente y el Análisis del Ciclo de Vida.
En 2017 es elegido vicepresidente de la Asociación de Químicos de Madrid. En 2020 es nombrado vocal del Consejo Social de la Universidad Complutense de Madrid.
Historial académico laboral
2015-2021: concejal del Ayuntamiento de Boadilla del Monte.
Profesor de la Universidad CEU – San Pablo desde 1995 hasta 2016. En esta Universidad obtiene en 2011 el grado académico de Catedrático de Universidad Privada en Ingeniería. 2002- 2016: director de posgrados y Másteres Oficiales Universitarios en Energías Renovables, en Prevención de Riesgos Laborales y en Gestión Integrada de la Calidad, la PRL y el Medioambiente.
2009-2016: director del Programa de Doctorado en Energías Renovables. En septiembre de 2016 pasa a la Universidad a Distancia de Madrid (UDIMA) como catedrático de Universidad Privada en Ingeniería Química.
Julio de 2021- julio de 2023: director General de Universidades y Enseñanzas Artísticas Superiores del Gobierno de la Comunidad de Madrid.
Julio de 2023: vuelve a la cátedra de ingeniería en la Universidad San PabloCEU y es nombrado director Académico de la Fundación Universitaria CEUNúñez de Balboa.
En enero de 2024 es elegido decano – presidente del Consejo General de Colegios Oficiales de Químicos de España.
Investigador principal en 17 proyectos de financiación pública y privada, gestionando en total más de 1,4 millones de EUR en investigación. Autor de 6 patentes (5 con licencia de explotación industrial), 1 modelo de utilidad industrial y de más de 70 publicaciones científico - técnicas (libros y artículos)
Director de 24 tesis doctorales en 5 universidades públicas y privadas; obteniendo en todas ellas la máxima calificación cum laude
Tres sexenios de investigación reconocidos en los tramos 2000/2006, 2011/2017, y 2018/2023 (último “sexenio vivo”), y un sexenio de transferencia del conocimiento y la innovación reconocido en el tramo 2009/2015. Total: 4 sexenios (investigación y transferencia).
Premios y distinciones
· Premio Ángel Herrera de la Fundación Universitaria San Pablo – CEU a la mejor labor docente en 2004.
· Íd. a la mejor labor de investigación en 2008.
· Íd. Íd. en 2011.
· Premio Nacional de Prevención de Riesgos Laborales en 2012 (PREVER 2012).
· Medalla de Oro del Foro Europa 2001 al mérito profesional en 2013.
· Medalla de Oro con distintivo rojo al Mérito Profesional del Consejo General de Relaciones Industriales y las Ciencias del Trabajo en 2014.
· Medalla de Oro con distintivo verde al Mérito Profesional del Consejo General de Profesionales de Seguridad y Salud en 2015.
· Premio Mutualia a la mejor investigación en Prevención de Riesgos Laborales en 2016.
· Finalista en los Premios de Fomento Nacional del Trabajo 2016.
· Premio V Edición SCMST al mejor trabajo en Salud Laboral y Prevención de Riesgos de la Sociedad Castellana de Medicina y Seguridad en el Trabajo en 2016.
· Socio de honor de ARQUICMA (Asociación de Químicos y profesionales de la Industria de Castilla – La Mancha) 2016.
· Premio de la Sociedad Española de Salud y Seguridad en el Trabajo 2018 a la mejor trayectoria profesional.
· Cruz de Honor del Consejo General de Profesionales de Seguridad y Salud en el Trabajo (2019).
· Cruz de los Servicios Distinguidos de las Relaciones Industriales y Ciencias del Trabajo (2020).
· Premio Nacional de I+D+i en Prevención de Riesgos Laborales en 2020 (PREVER 2020).
· Colegiado Distinguido del Colegio de Químicos de Madrid (2021).
· Medalla de Oro al Mérito Profesional de la Sociedad Castellana de Medicina y Seguridad en el Trabajo (2022).
Ricardo Díaz Martín tiene 58 años, está casado y tiene dos hijos.
instituciones
Xavier Bautista
Fuentes:
Ministerio de Ciencia, Innovación y Universidades y CSIC.es
El Consejo Superior de Investigaciones Científicas (CSIC) es la principal institución pública en España dedicada a la investigación científica y técnica. Desempeña un papel fundamental en el desarrollo y la promoción de la ciencia en el país. Por su evolución y disciplinas que abarca constituye un pilar básico de la ciencia y la tecnología españolas.
La investigación en el CSIC se extiende en tres áreas globales, Sociedad, Vida y Materia, y cuatro ejes de conexión entre las mismas (S-V, S-M, V-M, S-V-M), que permiten llevar a cabo investigaciones interdisciplinares, iniciativas de excelencia y de transferencia, y abordar temas de frontera en prácticamente todas las áreas de conocimiento.
La sinergia entre los diferentes centros e institutos a través de los grupos de investigación permite participar en nuevos retos y convierte al CSIC en un actor clave en la investigación internacional con un reconocido carácter de innovación. Los más de 120 institutos del CSIC realizan investigación básica y aplicada al servicio de la sociedad centrada en desarrollos científicos pioneros. Las plataformas temáticas interdisciplinares orientadas a la resolución de grandes retos globales de alto impacto social y científico, con un carácter de misión y una perspectiva temporal, representan las nuevas iniciativas para explotar la capacidad entre áreas trabajando de forma conjunta y coordinada, y promover propuestas lideradas por jóvenes.
Historia de la institución
El CSIC fue creado el 24 de noviembre de 1939 mediante una ley publicada en el Boletín Oficial del Estado (BOE) el 28 de noviembre del mismo año. Esta institución surgió como heredera de la Junta para Ampliación de Estudios e Investigaciones

Científicas (JAE), establecida en 1907 y presidida por Santiago Ramón y Cajal.
La JAE tenía como objetivo principal conectar la ciencia y la cultura españolas con Europa, promoviendo la modernización del país mediante la educación y la investigación. Sin embar-
instituciones
go, tras la Guerra Civil, el nuevo régimen consideró necesario reorganizar la estructura científica del país, lo que llevó a la disolución de la JAE y la creación del CSIC.
La creación del CSIC respondió a la intención del régimen franquista de controlar y dirigir la investigación científica bajo principios ideológicos afines. Se buscaba restaurar la “clásica y cristiana unidad de las ciencias”, según se menciona en la ley fundacional del CSIC. Además, se pretendía revitalizar la tradición científica española y fortalecer el “imperio espiritual de España”. Estas motivaciones reflejaban una visión de la ciencia subordinada a los valores y objetivos del régimen.
Momentos y personajes clave en la historia del CSIC
- 1942: se modifica por primera vez la ley fundacional, estableciendo un sistema de colaboración con las universidades y permitiendo la creación de institutos mixtos.
- 1945: se aprueban las primeras plazas de personal propio de investigación y de apoyo, consolidando la estructura interna del CSIC.
- décadas de 1960 y 1970: el CSIC se expande geográficamente, estableciendo centros e institutos de investigación en diversas regiones de España y abriendo su primera sede en el

extranjero: la delegación del CSIC en Roma.
- 1977: con la llegada de la democracia, se publica un nuevo reglamento que rompe con la etapa anterior y sienta las bases para las regulaciones futuras del CSIC.
- Santiago Ramón y Cajal: primer presidente de la JAE y figura emblemática en la ciencia española, tras serle concedido el Nobel de Fisiología/Medicina en 1906.


Entre las labores del CSIC también se cuentan la divulgación y la difusión científicas
- José Ibáñez Martín: fue el ministro de Educación que presidió el CSIC en sus inicios, desempeñando un papel crucial en su fundación y orientación inicial.
- José María Albareda: como secretario General del CSIC, colaboró estrechamente con Ibáñez Martín y tuvo una influencia significativa en la dirección del organismo durante sus primeros años.
científicas que abarca el CSIC
El CSIC es una institución multidisciplinaria que abarca una amplia gama de áreas del conocimiento, que se pueden agrupar en diferentes ámbitos:
- Ciencias humanas y sociales, con disciplinas como Historia, Filosofía, Filología, Economía y Sociología.
- Ciencias y tecnologías físicas: Física teórica y aplicada, Matemáticas y áreas relacionadas.
- Ciencias y tecnologías de materiales: investigación de nuevos materiales y sus aplicaciones.
- Ciencias y tecnologías químicas: Química orgánica, inorgánica y otras ramas de la Química.
- Ciencias de la vida: Biología, Biomedicina y disciplinas afines.
- Ciencias agrarias: investigación agrícola y forestal.
- Ciencias del mar: Oceanografía, Biología marina y temas relacionados.
- Ciencias y tecnologías ambientales: estudio y solución de problemas ambientales.
Liderazgo actual del CSIC
En junio de 2022, Eloísa del Pino Matute fue nombrada presidenta del CSIC. Doctora en Ciencia Política por la Universidad Complutense de Madrid y licenciada en Derecho y Ciencias Políticas, ha desarrollado una destacada carrera en el ámbito académico y en la administración pública. Ha sido investigadora
visitante en instituciones como la Universidad de Oxford y ha centrado su investigación en políticas públicas y su evaluación, así como en el estado del bienestar.
Al asumir la presidencia del CSIC, Del Pino expresó su compromiso de actuar en tres ámbitos principales:
- Mejora de las condiciones laborales: buscar la estabilidad y el reconocimiento adecuado para el personal investigador y de apoyo.
- Reducción de cargas burocráticas y administrativas: agilizar los procesos internos para facilitar la labor investigadora.
- Actualización de las estructuras organizativas y de gobernanza: adaptar el CSIC a los desafíos contemporáneos y fortalecer su papel en el sistema público de ciencia.
Disciplinas técnicas de laboratorio en el seno del CSIC
Dentro del CSIC, varias instituciones e institutos se especializan o trabajan intensamente con técnicas de laboratorio, abarcando desde la Biomedicina hasta la Química, los materiales o la nanotecnología.
Estas instituciones cuentan con infraestructuras punteras y laboratorios altamente especializados que ofrecen soporte tanto a investigaciones internas como colaboraciones externas. Además, muchas de ellas forman parte de plataformas científicas del CSIC, como el Centro Nacional de Microscopia Electrónica o las Unidades de Técnicas Instrumentales Avanzadas (UTIA).
Estas son algunas de las más destacadas, la mayoría radicadas en Madrid:
- El Instituto de Química Física Rocasolano (IQFR): está ubicado en Madrid. Sus especialidades son la Espectroscopia, la Cristalografía, la Dinámica molecular y la Biofísica. En sus
instituciones
laboratorios tratan técnicas de microscopia, RMN y difracción de rayos X, entre otras.
- El Centro de Investigaciones Biológicas Margarita Salas (CIB-CSIC) también está en Madrid. Sus especialidades son la Biología molecular, la Bioquímica, la Biotecnología y la Biología estructural. En sus laboratorios emplean técnicas para los cultivos celulares, la proteómica, la microscopia confocal y la genómica.
- El Instituto de Biomedicina de Valencia (IBV-CSIC) tiene entre sus especialidades la investigación biomédica básica y aplicada. Trata Biología celular, análisis genético, modelos animales o citometría de flujo.
- El Instituto de Microelectrónica de Madrid (IMM-CSIC) está especializado en nanotecnología, microelectrónica y sensores. Trabaja con litografía, microscopia electrónica y deposición de capas delgadas, entre otras.
- El Instituto de Ciencia de Materiales de Madrid (ICMMCSIC) está especializado en caracterización de materiales, nanociencia y magnetismo. Trata AFM, SEM, TEM y espectroscopias avanzadas.
- El Instituto de Química Médica (IQM-CSIC) está especializado en diseño de fármacos y Química farmacéutica. Sus laboratorios trabajan en síntesis orgánica, ensayos biológicos y análisis químico.
- El Instituto de Recursos Naturales y Agrobiología de Sevi-
lla (IRNAS-CSIC) cuenta entre sus especializades con la Edafología, nutrición vegetal y microbiología ambiental. Utiliza técnicas analíticas de suelos, análisis elemental y espectrofotometría.

La Biomedicina es una de las disciplinas en la que están especializadas diferentes instituciones englobadas en la estructura del CSIC

175 years of Leybold
Innovative companies often have an interesting history. One tradition-conscious market leader is the German vacuum specialist Leybold. Founded by Ernst Leybold in Cologne in 1850, the company has achieved numerous pioneering milestones and product developments. Now, in 2025, this manufacturer is celebrating its 175th anniversary.
• Important role in many areas. Leybold’s core competencies include developing and manufacturing standardized, individual solutions for vacuum generation and process gas conveying, as well as customer-specific vacuum systems. The vacuum pioneer’s components, systems, and services play an important role in many areas worldwide, such as industrial coating, analysis, and R&D processes.
• Dynamic markets, high demands. With its comprehensive application expertise and the quality of its products and services, Leybold has a significant influence on the efficiency of processes and value chains. This is particularly important now because the market dynamics and global challenges, such as climate change, are especially great.
• Areas of application undergoing structural change. The currently relevant applications of vacuum technology in structural change include metallurgy, the automotive and coating industries, solar, display and food applications, analytics and processes to produce lithium-ion batteries for electromobility.
• Continuation of the Leybold name. The entrepreneur Ernst Leybold laid the foundations for the company when he moved from Bavaria to the Rhineland in 1850. By registering the company in Cologne, Leybold became the founder of industrial vacuum technology. Even after the sale of the company in 1870, which continued to operate under the name “E. Leybold’s Nachfolger’, his vision remained intact.
• Collaboration with Dr. Wolfgang Gaede. His successors achieved a breakthrough in vacuum technology in 1906 in collaboration with Dr. Wolfgang Gaede: for example, with


the basic principle of the turbomolecular pump (1911) and the application of the diffusion pump (1913), both of which are still in use today. The gas ballast device for pumping out vapours, patented in 1935, is also still in use.
• Industrial utilization of the vacuum. Vacuum metallurgy began in 1913: Dr. Wilhelm Rohn, head of the physical testing laboratory at W.C. Heraeus GmbH, developed a process for melting high-purity metals in a vacuum in Hanau, which was patented in 1918. In 1931, Wilhelm Carl Heraeus succeeded in vaporizing metals on glass, thus paving the way for vacuum coating technology. Subsequently, vacuum technology was increasingly used in process engineering.
• Important brand with great appeal. In September 2016, the Swedish company Atlas Copco AB, based in Stockholm, acquired 100% of Oerlikon Leybold Vacuum, which is now part of Atlas Copco’s Vacuum Technique division. In the multibrand group with around 53,000 employees and customers in over 180 countries, Leybold is a major brand that plays an important role with its great tradition and reputation.
Cambios en su organigrama en busca de crecimiento y fortalecimiento
Feria de Zaragoza, referente nacional e internacional en la organización de eventos y exposiciones, anuncia cambios en su organigrama como parte de su estrategia de crecimiento y fortalecimiento. Los órganos de gobierno de Feria de Zaragoza adoptaron la decisión de constituir una dirección General Adjunta, como apoyo estratégico a la dirección General y con responsabilidad directa en el ámbito Comercial integrando, en dicha D. Gral. Adjunta, el departamento de Desarrollo de Negocio, así como el de Transformación Digital y el de Marketing y Comunicación. Con el objetivo de fortalecer su estrategia de crecimiento y buscando una mayor eficiencia en la gestión, la nueva directora General Adjunta, Ana Hernández Serena, asume en primera persona la dirección de Desarrollo de Negocio. Feria de Zaragoza expresa su agradecimiento al hasta ahora director de Desarrollo de Negocio, Alberto López, por su destacada labor a lo largo de estos años, reconociendo los importantes logros alcanzados bajo su dirección. Estos cambios marcan una nueva etapa para Feria de Zarago-
za, y la institución reafirma su compromiso de seguir siendo un motor de desarrollo económico y social para Aragón y para todos los sectores que representa.
www.feriazaragoza.es


OHAUS
Innovación sostenible en el aprovechamiento del café molido
En el corazón de Polonia, EcoBean allana el camino hacia un futuro sostenible reduciendo el impacto ambiental en la industria química y del café. El café molido es una materia prima muy valiosa, que actualmente acaba principalmente en vertederos. Solo se usa el 30% del potencial de los granos de café en cafeterías u hogares durante la preparación de bebidas, mientras que el 70% restante se oculta en los residuos de café.
EcoBean, empresa derivada de la Universidad Tecnológica de Varsovia, se compromete a cerrar el círculo del café e introducir productos químicos derivados del café molido usado con la menor huella de carbono posible. Su solución combina una innovación biotecnológica de vanguardia, un compromiso con el impacto ambiental positivo y un enfoque empresarial.
· Soluciones innovadoras y economía circular
EcoBean trabaja en la emocionante intersección entre tecnología y gestión ambiental. Su modelo de negocio único implica recoger el café molido usado y procesarlo en cinco fracciones de productos químicos que se pueden utilizar en varios segmentos industriales, como los cosméticos, los fármacos, los alimentos, los piensos o los envases.
El proceso desarrollado aborda dos retos urgentes: el creciente problema de la generación de residuos y la mayor demanda de materias primas sostenibles. Esta solución no solo es eficaz y escalable, sino también práctica para que los clientes la implementen.
· Socio en la preparación de muestras y el control de calidad
Los productos de pesaje y equipos de laboratorio de OHAUS desempeñan un papel importante en el laboratorio de EcoBean, apoyando el trabajo diario con las materias primas (café molido) y los productos obtenidos a partir de su procesamiento.
Además, los productos de OHAUS
permiten a EcoBean obtener un control de calidad preciso y facilitar el trabajo de optimización en el desarrollo de la tecnología de procesamiento del café molido usado.
EcoBean utiliza balanzas analíticas y balanzas de precisión Pioneer™ (PX224M/1 y PX4201M/1) para el pesaje de materias primas de muestra, así como de productos finales. También usa el analizador de humedad MB90 para determinar el contenido de agua, así como la centrífuga Frontier™ FC5706 y los agitadores magnéticos con calefacción Guardian™7000 (e-G71HS07C) para preparar las muestras. Esta sólida selección de herramientas permite a EcoBean mantener la uniformidad y la repetibilidad en sus protocolos de laboratorio, lo que es crucial para cumplir con los estándares de la industria.
Por ejemplo, cuando una muestra está más caliente que el entorno circundante, pueden crearse corrientes de convección o producirse diferencias en la densidad del aire que afecten a las lecturas de la balanza. Por el contrario, si una muestra está más fría, puede producirse condensación, así como cambios en las propiedades físicas de la muestra que influyen en los resultados de la medición.
· Opinión del especialista de EcoBean El equipo de I+D de EcoBean considera que los equipos de OHAUS son muy útiles en sus operaciones diarias en el laboratorio. Como indica, “el equipo de OHAUS satisfizo todas nuestras necesidades básicas. El uso fue sencillo e intuitivo y, lo que es más importante, mejoró la repetibilidad de los resultados de los análisis”.
· Elaborando un futuro sostenible EcoBean es más que una simple empresa tecnológica: su objetivo es impulsar la innovación y la sostenibilidad. Al aprovechar la tecnología de vanguardia y asociarse con proveedores de confianza como OHAUS, EcoBean
está preparada para tener un impacto duradero en el medioambiente al mismo tiempo que establece nuevos estándares en el uso de café molido. Su trayectoria es el ejemplo del potencial de la economía circular y sirve de inspiración para futuros emprendimientos centrados en la sostenibilidad y la responsabilidad ambiental.
Con sede en Parsippany, Nueva Jersey (EE.UU.), OHAUS Corporation fabrica una amplia línea de balanzas y básculas electrónicas y mecánicas de alta precisión que cumplen las demandas de prácticamente cualquier necesidad de pesaje. La empresa destaca en los canales de laboratorio, industriales y educativos, así como en numerosos mercados especializados, incluidas las industrias alimentaria, farmacéutica y de joyería. Como fabricante certificado según la norma ISO 9001:2008, sus productos son precisos, fiables y asequibles, y están respaldados por una asistencia al cliente líder en su sector.
www.ohaus.com
(Véase anuncio en la sección Guía del Comprador.)

NOVARTIS
Presentaciones de datos en la AAAAI y la AAD
Novartis ha anunciado que presentará datos de 17 abstracts, incluyendo estudios iniciados por investigadores, de toda su cartera de productos de inmunología, en la Academia Americana de Alergia, Asma e Inmunología (AAAAI, por sus siglas en inglés) y la Organización Mundial de Alergia (WAO, por sus siglas en inglés) de 2025 y en la Reunión Anual de la Academia Americana de Dermatología (AAD, por sus siglas en inglés) de 2025.
Los datos presentados en los congresos incluyen el control de la urticaria a largo plazo, el sueño y de actividad de los estudios de Fase III REMIX-1 y REMIX-2 que evalúan remibrutinib en investiga-
ción para el tratamiento de la urticaria espontánea crónica (UCE). Además, se presentarán datos a largo plazo de los estudios de Fase III SUNSHINE y SUNRISE de Cosentyx® (secukinumab) en pacientes con hidradenitis supurativa (HS) y los resultados notificados por los pacientes de un estudio de Fase II que evalúa remibrutinib en HS.
“Enfermedades como la UCE y la HS van más allá de la superficie de la piel y a menudo tienen un profundo impacto en la vida y las actividades diarias de los pacientes”, afirma Angelika Jahreis, directora global de Desarrollo de Inmunología de Novartis. “Estos datos en la AAAAI y la AAD resaltan
nuestro compromiso continuado de reimaginar la medicina y abordar las brechas de tratamiento para las personas con enfermedades inmunomediadas. Estamos especialmente emocionados por el potencial de remibrutinib como un nuevo tratamiento de administración oral para pacientes con UCE que siguen siendo sintomáticos con antihistamínicos”.
Estos datos acerca de la UCE respaldarán las solicitudes de registro en la primera mitad de 2025. Además de la UCE, se está investigando remibrutinib en otras enfermedades inmunomediadas, entre ellas la urticaria crónica inducible (UCInd), la HS y la alergia alimentaria.

Lauda lanza la garantía ampliada de 5 años
Lauda Dr. R. Wobser GmbH & Co. KG, líder mundial en el sector de la regulación exacta de la temperatura, refuerza su compromiso con la calidad con un atractivo paquete de garantías: La empresa ofrece ahora una garantía de cinco años para los equipos de termorregulación registrados. Esto subraya el compromiso y la confianza de Lauda en sus propios productos.
· Compromiso de calidad atractivo para los clientes. “Estamos tan convencidos de nuestra calidad que ofrecemos una garantía de cinco años para los equipos de termorregulación registrados”, explica el Dr. Gunther Wobser, presidente & CEO de la firma. “Esta garantía es la expresión de nuestra estrategia de calidad sin concesiones y de nuestra confianza en la durabilidad de nuestros equipos”.
Tras el registro, el nuevo compromiso de garantía se aplica a numerosos equipos de termorregulación de las líneas de equipos actuales de la gama de productos en serie, incluidos los nuevos termostatos de baño Lauda Universa.
· Registro sencillo, condiciones claras. Esta garantía se aplica a partir de la fecha de entrega. Para ello, el registro debe rea-
lizarse en un plazo de tres meses a partir de la entrega del equipo y lo puede efectuar fácilmente el cliente final en la plataforma de servicios LAUDA.LIVE. Durante el periodo de garantía y en cumplimiento de las condiciones de garantía, como la compra del equipo a través de Lauda o de socios autorizados y el uso exclusivo de líquidos caloportadores Lauda, el fabricante cubrirá los costes de mano de obra y material de todas las reparaciones.
· Servicio internacional garantizado. La garantía está disponible en todos los países participantes. Las reparaciones se realizan en la fábrica de Lauda-Königshofen o en centros de socios de servicio autorizados. “Con este compromiso de garantía, no solo subrayamos la calidad de nuestros productos, sino también nuestra filosofía de servicio”, subraya el Dr. Wobser. “Nuestros clientes pueden confiar en que sus equipos de termorregulación Lauda funcionarán de forma fiable durante muchos años”.
· Sostenibilidad y visión de futuro. La garantía, que va mucho más allá de la garantía legal, se aplica a una amplia gama de productos, incluida la última generación de equipos de termorregulación con
refrigerantes naturales. De este modo, Lauda combina sostenibilidad con durabilidad y subraya su intención de ser el líder tecnológico y de calidad en la tecnología de regulación de temperatura. Los equipos e instalaciones de termorregulación de Lauda son la parte fundamental de aplicaciones importantes y contribuyen a mejorar el futuro. Proveedor integral, garantiza la temperatura óptima en la investigación, la producción y el control de calidad. Es el socio en que confiar para la electromovilidad, el hidrógeno, las industrias química, farmacéutica/biotecnológica y de semiconductores, así como de la tecnología médica. Gracias a su asesoramiento competente y a unas soluciones innovadoras, lleva casi 70 años entusiasmando cada día de nuevo a clientes de todo el mundo. La empresa va siempre un paso por delante. Lauda impulsa a sus empleados y se desafía constantemente: por un futuro mejor que forjan juntos.
www.lauda.de/es
(Véase anuncio en la sección Guía del Comprador.)

Lauda redobla la apuesta: 5 años de garantía en gran parte de su gama de productos con efecto inmediato (© Lauda)
Boehringer Ingelheim se asocia con Veeva para lanzar “One Medicine Platform”
Boehringer Ingelheim y Veeva Systems anuncian el lanzamiento de One Medicine Platform de Boehringer, impulsada por la exitosa implementación de Veeva Development Cloud. La colaboración para One Medicine fue anunciada por primera vez en marzo de 2022. Esta plataforma unificada integra datos y procesos en las áreas clinical, regulatoria y de calidad, permitiendo a Boehringer agilizar el desarrollo de sus productos. Con One Medicine Platform, Boehringer puede conectar a la perfección los datos de todas las funciones, optimizar la eficiencia de los ensayos y la colaboración con los centros de investigación y acelerar la distribución de nuevos medicamentos para tratar enfermedades hoy incurables.
“Junto a Veeva, Boehringer ha avanzado en su enfoque de los ensayos clínicos y está cumpliendo nuestro compromiso de acelerar la implementación de tratamientos innovadores que transformen la vida de los pacientes en todo el mundo”, asegura Oliver Fink, head of learning, process and digitalization en Boehringer Ingelheim. “Veeva Development Cloud proporciona la base tecnológica para One Medicine Platform de Boehringer, dando a nuestros equipos la flexibilidad para diseñar y ejecutar estudios con mayor velocidad, eficiencia y compliance”.
“Al conectar las áreas de clinical, regulatoria y de calidad en Veeva Development Cloud, Boehringer unifica los datos y rompe los silos entre los equipos para acelerar el desarrollo y las autorizaciones de medicamentos” comenta Rik van Mol, senior vice president, Veeva Development Cloud. “Este es un hito emocionante hacia la consecución de la misión compartida de Veeva y Boehringer para avanzar en el uso de datos y tecnologías que modernicen los ensayos clínicos y ofrezcan mejores resultados a pacientes”.
Veeva Development Cloud es la base tecnológica para el desarrollo de productos, que reúne aplicaciones de clinical, calidad, normativas y de seguridad para simplificar los procesos empresariales integrales y ofrecer excelencia en los procesos.
Veeva es líder mundial en software en la nube para el sector de las ciencias de la salud. Comprometida con la innovación, la excelencia de sus productos y el éxito de sus clientes, da servicio a más de 1.000 clientes, desde las mayo-
res empresas farmacéuticas del mundo hasta biotecnológicas emergentes. Como ‘Public Benefit Corporation’, Veeva se compromete a equilibrar los intereses de todas las partes interesadas, incluyendo clientes, empleados, accionistas y las industrias a las que sirve.
Boehringer Ingelheim es una compañía biofarmacéutica activa tanto en salud humana como animal. Como uno de los principales inversores de la industria en I+D, la
compañía se centra en el desarrollo de terapias innovadoras en áreas de alta necesidad médica no cubierta. Independiente desde su fundación en 1885, Boehringer adopta una perspectiva a largo plazo, integrando la sostenibilidad a lo largo de toda la cadena de valor. Más de 53.500 empleados trabajan en más de 130 mercados para construir un mañana más sano, sostenible y equitativo.
























































































1. Los trabajos se remitirán al Departamento de Redacción de la revista (Publica, S.L., C/ Monturiol, 7, local 1 - 08018 Barcelona / miguel@publica.es) junto con una autorización para su publicación. Estudiado el trabajo por el Comité de Redacción, se acusará el recibo con la aceptación o no del mismo. Se devolverán (si los autores lo solicitan) las colaboraciones que no se ajusten, por su contenido, a la temática de la revista.
2. Texto y presentación: los artículos estarán preferentemente en castellano (también se aceptarán en inglés) y no sobrepasarán el equivalente a 10 DIN A4 (sin contar gráficos y/o figuras). Se estudiará la publicación fragmentada de artículos más extensos. Se ruega utilizar los editores más comunes del mercado (Word, OpenOffice...). Si el trabajo incluye imágenes o fotografías se aportarán en archivos aparte (JPG, TIF, PDF….) y deberán estar escaneadas a una resolución mínima de 300 ppp. En cualquier caso se solicita, si es posible, el envío de un ejemplar en soporte papel.
En el encabezamiento de la colaboración constarán su título, el nombre y los apellidos de los autores y el centro o empresa (si procede) donde se ha realizado el trabajo. Los artículos se acompañarán de un resumen que señale el objeto del trabajo, algún detalle experimental, si se estima oportuno, y las conclusiones obtenidas. A ser posible, el título y este resumen se incluirán también en inglés si el artículo está en castellano. La bibliografía se incluirá al final del texto, numerada correlativamente y consignando en cada cita apellido e inicial(es) del autor, año de publicación, título y nombre de la publicación. Las referencias numéricas a la bibliografía se escribirán en el texto del trabajo entre paréntesis. Los pies de gráficos, figuras y fotografías se presentarán juntos, por orden y en párrafo aparte al final del artículo.
3. Tablas, gráficos y figuras. Se pide la máxima pulcritud en la realización de tablas y gráficos para conseguir una reproducción del original lo más fiel posible. Los gráficos (esquemas, croquis y dibujos en general), si no se presentan en soporte informático directamente utilizable, se prefieren por este orden: reproducciones bien impresas; originales realizados sobre papel; fotocopias de alta calidad, en tamaños iguales o superiores a los deseados para su publicación y teniendo en cuenta que el factor más importante es, en este caso, el contraste de las imágenes. Las fotografías, si no se proporcionan en soporte informático o vía correo electrónico, se prefieren por este orden: copias en papel fotográfico en color o B/N; diapositivas o transparencias en color o B/N y, finalmente reproducciones bien impresas. Las tablas, gráficos y figuras se presentarán al final del artículo. Las referencias numéricas de las figuras se citarán en el texto cuando corresponda.
4. Los autores recibirán sin cargo un ejemplar de la revista en que haya aparecido su colaboración. Si desean más ejemplares (hasta 10) lo harán constar en la carta que acompañe al trabajo. Se estudiarán otras condiciones de envío de ejemplares a petición de los autores.
5. Estas normas no afectan (aunque son una buena orientación) a colaboraciones como noticias de empresa, descripciones de nuevos aparatos y equipos, programas de actos y congresos, ferias, salones y jornadas, reseñas de libros, artículos de opinión, etc.
6. Si desean ampliar esta información pueden utilizar el teléfono +34 933 215 045 o el e-mail citado.





Life Science / Biotecnología
ID N.º 38653
Becton Dickinson BBL Becton Dickinson
BBL Crystal Autoreader
Incluye: lámpara UV, placa de referencia, interfaz de datos serial. Software:
BBL Crystal MIND V 5.03 A en CD y disquete de 3,5”. 230 V, 50/60 Hz 1.712 €
1.626,40 €

Life Science / Biotecnología

ID N.º 38776
Sakura Impresora Tissue-Tek AutoWrite
Para casetes y portaobjetos. El módulo de descarga puede clasificar automáticamente hasta 110 portaobjetos o casetes.Velocidad de impresión: hasta 900 casetes o 800 portaobjetos por hora. 230 V, 50/60 Hz, 700 W. Incluye accesorios. 3.424 €
2.739,20 €
Hematología

ID N.º 38780
Cromatografía Líquida de Alta Resolución (HPLC)
ID N.º 38909

Waters HPLC 2695
Incluye: Detector de absorción dual Waters 2487, autosampler con 5 bandejas de 72 muestras cada una, bandeja para solventes, tarjeta de red, panel de control con teclado numérico, monitor LCD, unidad de disquete de 5 1/4”, varios cables de conexión. 230 V, 50/60 Hz. 8.453 €
6762,40 €
Cromatógrafo de iones
ID N.º 38853

Cromatógrafo de iones Dionex IC 20
Detector electroquímico ED 40, bomba de gradiente GP 50, autosampler AS 50, compartimento térmico AS 50, horno de cromatografía LC 25, 2 bombas de jeringa, columnas. 8.132 €
6.912,20 €
Fótometro / Espectrofotómetro

ID N.º 38822
Espectrofotómetro Thermo Electron
Genesys 10 VIS
Rango espectral: 325-1100 nm. Soporte de cubetas termostatizable. Termostato de inmersión (circulación) Julabo ED con baño de agua. Software incluido. 100-240 V, 60 Hz / 230 V, 50/60 Hz, 2000 W.
1.829,70 €
Cromatografía Líquida de Alta Resolución (HPLC)
ID N.º 39077
HPLC Amersham ÄKTAexplorer
Incluye: bandeja Tray Box-900, monitor de eluyentes pHC-900, detector UV UV-900, bomba P-900, controlador de red CU-950. 230 V, 50/60 Hz, 600 W. 15.700 €
13.345 €

Cromatografía Líquida de Alta Resolución (HPLC)
ID N.º 39090
Dionex HPLC UltiMate
3000
Compuesto por: estante para solventes con desgasificador SRD-3600, bomba de gradiente DGP-3600A, autosampler WPS-3000TSL Analytical con bucle de muestra de 100 µL, horno para columnas TCC-3200 2x2P-10P, detector VWD-3400. 230 V, 50/60 Hz, 750 W. Mantenido anualmente por Thermo Scientific.

Hematología
ID N.º 39166
Nefelómetro Dade Behring BN ProSpec 60-70 pruebas por hora. Compartimento de almacenamiento integrado y refrigerado para reactivos. Compatible con STAT. PC incluido. Software BN ProSpec System en CD. Diversos accesorios. 230 V, 50/60 Hz, 450 W. 4.500 €
3.375 €

Cromatógrafo de gases
ID N.º 39111
Bruker Headspace-Sampler SHS-40
Panel de control con membrana, carrusel de 40 posiciones, pantalla LCD retroiluminada. Interfaces: RS232 y control remoto. Presión de entrada: máx. 6,5 bar. 230 V, 50/60 Hz, 600 W.

Cromatografía Líquida de Alta Resolución (HPLC)
ID N.º 39326
Agilent HPLC 1100. Compuesto por una bandeja, desgasificador G1322A, bomba binaria G1312A, autosampler G1313A, termostato, horno para columnas G1316A y detector VWD G1314A. 230 V, 50/60 Hz, 970 W. 11.800 €
11.210 €

Cromatografía Líquida de Alta Resolución (HPLC)
ID N.º 39391

Sistema de carga de muestras Thermo
Scientific Vanquish Charger
Para la serie UHPLC Vanquish. Capacidad para 8,832 muestras (23 microplacas). Totalmente integrado.
Rango de temperatura: 4-40 °C.
230 V, 50/60 Hz, 350 W.
Bombas de vacío
ID N.º 39748
Bomba de vacío
Edwards E2M30
Con filtro de neblina de aceite EMF 20. Velocidad de rotación: 1450/1740 rpm.
230 V, 50/60 Hz, 750/900 W. 2.800 €
2.660 €

Secuenciador de ADN
Duración de la promoción: hasta el 31/05/2025. Precios sin IVA, no incluyen los gastos de flete y embalaje, Sujeto a venta previa, toda la información sin garantía, sin responsabilidad por errores de impresión.

ID N.º 39854
Shimadzu TOC-Analyzer TOC-V CSH.
Con muestreador OCT-1, PC, monitor, teclado y ratón. Software: TOC V Rev. 1.06.00 y archivos de parche SP1. Panel de control con membrana y teclado numérico, 6 teclas de función, impresora térmica integrada.
110 V, 6 A.
7.700 €
5.775 €
Incubadoras de CO2
ID N.º 40028
Incubadora de CO2 EuroClone
SafeGrow 188 Pro

Rango de temperatura: 10-50 °C. Rango de CO₂: 0,5-20 % CO₂. Conexión de CO₂ con presión de entrada de 1 bar. Panel de control con membrana y pantalla digital. 4 bandejas extraíbles, pantalla protectora con cierre magnético y tirador de puerta. Patas ajustables en altura. 230 V, 50 Hz, 1600 W. 4.900 €
3.675 €
Termostatos / Criostatos
ID N.º 39013

Flujo laminar / Cabinas de seguridad

ID N.º 40063
Cabina de seguridad Holten Laminair
SHB 604
Cabina de seguridad con protección para el producto y el operador, Clase II. Pantalla con panel de control de membrana. Estructura inferior motorizada de metal. Frente deslizante motorizado. Paneles frontal y laterales de plexiglás. Iluminación interior y contador de horas de funcionamiento. Interior equipado con 2 tomas DK, 6 placas de trabajo de acero inoxidable segmentadas y extraíbles. 4 pasacables de Ø19 mm y 2 de Ø32 mm. Conexión de extracción de aire de Ø190 mm. Ancho exterior: 190 cm. 230 V.
5.600 €
3.360 €
Sistema-HPLC
ID N.º 39977
Agilent HPLC 1260
Infinity.
Valorador Metrohm 701 KF Titrino 3.750 € 3.000 €
ID N.º 40155
Refrigerador de circulación

Analizador genético Appl. Biosystems 3130 xl

Thermo Scientific ThermoFlex 10000
Rango de temperatura: 5-40 °C. Volumen del depósito: 17,9 L. Panel de control con membrana y pantalla digital. Indicador visual de nivel de llenado. 4 ruedas con 2 frenos de estacionamiento. 400 V, 50 Hz.
Con matriz capilar de 36 cm, software de análisis de secuenciación de ADN AB DNA Sequencing Analysis Software V 5.2, software de recopilación de datos Genetic Analyzer Data Collection Software V 3.0, SeqScape Software V 2.5, GeneMapper Software V 3.7, monitor, teclado y ratón. Incluye cables de conexión, interfaz Ethernet y conducto de extracción de aire de Ø 125
Desgasificador lineal de 2 canales PSS, bomba isocrática con enjuague posterior G1310B, autosampler G1329B, termostato ALS G1330B, horno para columnas G1316A, detector RI G1362A, detector UV-VIS G1314B, controlador Instant Pilot G4208A. SIN software.
230 V, 50/60 Hz, 1440 W.
Valoradores
ID N.º 39932


Compuesto por: agitador 703 Ti Stand con bomba, unidad intercambiable de 20 ml, teclado 701 KF, impresora Custom DP40H y botella de desecho de 900 ml. 230 V, 50/60 Hz, 15 W.
3.900 € 3.705 €

Labexchange es el proveedor líder de sistemas usados de laboratorio y análisis. Labexchange lleva más de 30 años siendo sinónimo de alta fiabilidad técnica con una amplia gama de servicios.



Material de laboratorio usado hasta un 55 % más barato que el precio nuevo anterior (Edad media de los equipos: 4 años)
Asesoramiento independiente, no ligado a ningún fabricante
Amplia selección de más de 6500 equipos de laboratorio nuevos y usados, así como mobiliario de laboratorio
Funcionalidad probada con informe de servicio detallado
60 días de garantía total y hasta un año de ampliación de garantía*
2 años de garantía de calidad*
Servicios competentes durante todo el ciclo de vida del equipo
Máxima rentabilidad y sostenibilidad
*Se aplican nuestros términos y condiciones específicos, que se pueden consultar en labexchange.com.
Labexchange
Bruckstr. 58 · 72393 Burladingen · Alemania
Tel. +49 (0)7475 9514-0 · Fax +49 (0)7475 9514-44 info@labexchange.com · www.labexchange.com


QUIERO COMPRAR LA NUEVA BALANZA CUANDO ESTÉ EN PROMOCIÓN
¡No espere! En Labbox no hacemos promociones porque si podemos bajar el precio, ese es el que decidimos aplicar todo el año.
MI PEDIDO SE HA PERDIDO
Reponemos la mercancía sin ningún coste para usted.
NECESITO LOCALIZAR MI PEDIDO
Haga seguimiento del pedido desde el email de tracking.
ME HA LLEGADO UN VASO ROTO
Le enviamos uno nuevo sin cargo alguno.
NECESITO PROGRAMAR ENTREGAS PERIÓDICAS
Una vez tengamos la programación nos encargamos de todo. FREE
PEDÍ TAPONES ROJOS Y LOS QUERÍA VERDES
Se los cambiamos sin coste.
NO PODRÉ CONFIRMAR EL PRESUPUESTO HASTA DENTRO DE DOS MESES
Tarifa de precios fija anual para ponérselo muy muy fácil.
PRECIOS
SIEMPRE BAJOS
HE COMPRADO UN AGITADOR PERO HE CAMBIADO DE IDEA
Se lo recogemos y abonamos sin ningún coste.
SE HA ESTROPEADO UN EQUIPO QUE OS COMPRÉ
Nuestro servicio técnico se ocupa de cualquier imprevisto.
Escanee para recibir el catálogo

ENTREGA RÁPIDA
SATISFACCIÓN O REEMBOLSO
Dispone de 15 días para devolver cualquier producto que no le satisfaga. 1 2 3
Nuestros precios no son ni “ofertas” ni “promociones”, son siempre igual de bajos.
Entregamos en un máximo de 48 h laborables en cualquier punto de España.
¡Más de 350 nuevas referencias!

www.labbox.es

19 años de experiencia
18.000 clientes colegios, universidades, instituciones públicas e industrias
+6.000 referencias de material de laboratorio
Distribuidores en más de 50 países
14 marcas propias especializadas por campos
+40.000 envíos al año
CIENCIAS
Envío gratuito a partir de 100 € sin IVA
Entrega en 24/48h Haga su pedido en
Material de uso general, material volumétrico, manejo de líquidos, filtración, separación y concentración, vidrio esmerilado, cromatografía, centrifugación, elementos de montaje e instrumental, frascos y recipientes, recogida de muestras, balanzas, agitadores, termostatización, combustión y calcinación, análisis de aguas y alimentos, instrumentos de medida y técnicas instrumentales, y mobiliario.





















Cultivo celular, biología molecular, microbiología y patología, microscopios, refrigeración y criogenización.




Equipos de protección, higiene y limpieza.



Reactivos y productos químicos.


